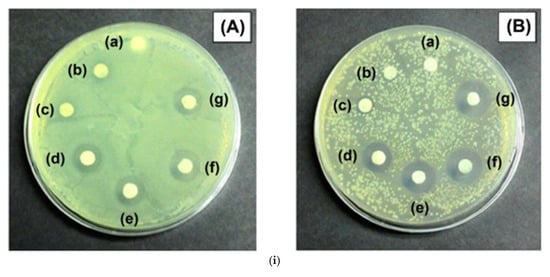
Micro 05 00037 g014a

Abstract
Over the last few decades, the growing demand for sustainable resources has made biopolymers increasingly popular, as they offer an eco-friendly alternative to conventional synthetic polymers, which are often associated with environmental issues such as the formation of microplastics and toxic substances. Functionalization of biomaterials involves modifying their physical, chemical, or biological properties to improve their performance for specific applications. Cellulose and bacterial cellulose are biopolymers of interest, due to the plethora of hydroxyl groups, their high surface area, and high porosity, which makes them ideal candidates for several applications. However, there are applications, which require precise control of their wetting properties. In this review, we present the most effective fabrication methods for modifying both the morphology and the chemical properties of cellulose and bacterial cellulose, towards the realization of superhydrophobic bacterial cellulose films and surfaces. Such materials can find a wide variety of applications, yet in this review we target and discuss applications deriving from the wettability control, such as antibacterial surfaces, wound healing films, and separation media.
1. Introduction
The widespread use of synthetic polymers and polymeric composites in several real-life and scientific applications such as construction materials [1], low friction materials [2,3], filtration membranes [4], and food packaging [5] has resulted in the production of plastic waste which has direct and indirect environmental effects [6]. Additionally, there is a rapid depletion of fossil fuels, though several recycling or recovery methods have been proposed [7]. There is also a significant demand for sustainable, plastic materials to replace non-biodegradable, synthetic polymers [8]. As a result, biomaterials, which are derived from renewable and degradable resources, can be a promising solution as they meet the required eligibility for green applications, offering renewable and biodegradable solutions with reduced environmental impact [9].
Biopolymers are natural long-chain polymers derived from living organisms that consist of bonded monomeric units and exhibit biodegradability which is attributed to the action of specialized enzymes and is further facilitated by the presence of oxygen and nitrogen atoms in the polymeric chain [10]. Representative examples of biopolymers include polysaccharides such as lignin, starch, cellulose, bacterial cellulose, and hemicellulose [11], as well as protein-based or microbial-derived biopolymers like gelatin, chitosan, and polyhydroxyalkanoates (PHAs). Except for their natural and sustainable character, their unique molecular architecture, which includes properties like a helical configuration and charge-neutral chains, makes them highly adaptable for advanced applications. Cellulose and bacterial cellulose have gained particular interest due to their remarkable properties such as their abundance of hydroxyl groups, high surface area and high porosity, which makes them ideal candidates for several versatile applications in fields like food packaging, healthcare, and environmental science.
However, the intrinsic properties of biopolymers are not sufficient for all the applications required and if they are to be applied as advanced materials and expand their applicability it is required to further process and functionalize them. Functionalization includes the modification of their physical, chemical, or biological characteristics to improve their performance for specific applications. Recent efforts have focused on the development of functional biopolymers in applications, such as a. wound healing [12], b. tissue engineering and c. drug delivery [13]. In wound healing and tissue engineering applications, the designs are mainly focused on how to maintain moisture balance, support tissue regeneration, and prevent bacterial infections, while being biodegradable and easy to apply [12,14]. d. biopolymers with antibacterial (antibiofouling—prevent bacterial adhesion by maintaining an air layer that inhibits microbial attachment) and bactericidal surfaces (kill bacteria through micro- or nano-structured topologies) and antiwetting properties which are important for food science, packaging and separation applications [15,16,17,18]. To this end, efforts reporting the development of cellulose-based materials with superhydrophobic properties (contact angles exceeding 150° and sliding angles below 10°) have been published [19,20,21].
To date, several review papers have been published in the field of biopolymers [22,23,24,25,26,27]. However, there is gap between cellulose and bacterial cellulose and how to achieve wetting control towards superhydrophobicity. This review aims to fill this gap by presenting the most effective methods for the in situ and the ex situ modification of both the morphological as well as the chemical properties of bacterial cellulose substrates targeting mainly wetting control and superhydrophobicity. Moreover, specific applications, such as antibacterial, separation and wound healing for functionalized cellulose and bacterial cellulose substrates are discussed. Finally, at the end of the manuscript, the most recent approaches are summarized and compared in terms of performance and sustainability, providing a comprehensive overview of the available technologies for the people working in this field.
2. Functionalization Methods for Cellulose and Bacterial Cellulose Membranes
As pointed out in the introduction section, functionalization is an important process to improve the properties of biopolymers to enable their use in a wide range of applications. Functionalization can be applied to either improve their intrinsic properties or to add completely new ones. In order to better understand how these biopolymers can be functionalized, it is important to understand their intrinsic nature and how they are produced [28]. Thus, in the following sections, first the properties of the cellulose and bacterial cellulose are presented, and then the existing wet and dry methods for modifying cellulose and bacterial cellulose are presented and compared in terms of effectiveness and scalability.
2.1. Cellulose and Bacterial Cellulose Properties and Production Methods
Cellulose is the most common, unlimited, low-cost polymer on Earth. As a polysaccharide, it is made up of repeating glucose units connected by glycosidic bonds. It forms the structural backbone of plant cell walls, providing rigidity and strength. As a result, it is a molecule consisting of hundreds to thousands of carbons, hydrogen, and oxygen atoms. Its biocompatibility, ecological sustainability, and diverse properties have made cellulose and its derivatives increasingly significant in various industrial and biomedical applications. Cellulose is a fibrous material of plant origin and serves as the foundation of all natural and synthetic cellulosic fibers. A homo-polysaccharide is made of β-1,4-anhydro-D-glucopyranose, each containing three hydroxyl groups (Figure 1), showing both excellent physical processability and high chemical reactivity [29]. The transformation of raw cellulose from plant biomass into a functional material suitable for advanced applications involves multiple structural and chemical modification steps. As illustrated in Figure 1, cellulose is initially synthesized within the plant cell wall in the form of microfibrils, which consist of polymer chains. Once extracted, cellulose undergoes purification to remove non-cellulosic components such as lignin and hemicellulose, followed by surface activation and functionalization through chemical or physical processes. These modifications are essential for improving key properties such as hydrophilicity, mechanical strength, and bioactivity. Depending on the intended applications, such as wound healing, drug delivery, or the development of superhydrophobic surfaces, different combinations of structural control and functional group incorporation are employed. After application, the biodegradability of cellulose ensures its return to the environment, reinforcing its role as a sustainable material in the circular bioeconomy. The term “cellulose” was first used in 1839 in a report of the French academy on the work of Anselme Payen. He discovered cellulose, a tough fibrous substance in plant tissues. He determined its molecular formula (C6H10O5) and noted its isomerism with starch [30]. It has been used for about 150 years as a chemical raw material until 1870 when Hyatt Manufacturing Company produced the first successful thermoplastic polymer called celluloid, by the formation of cellulose nitrate by reaction with nitric acid [31]. In that time, it was first produced on an industrial scale [32]. In 1920, Hermann Staudinger determined the polymer structure of cellulose [33]. In 1992, Kobayashi and Shoda first chemically synthesized cellulose fibers synthesized (without the use of any biologically derived enzymes) [34]. Cellulose fibers contain a large number of surface hydroxyl (OH) groups, which can easily form hydrogen bonds with water molecules, allowing water to spread across the surface. Cellulose is both a hydrophilic (water contact angle 20–50°) and hygroscopic material by nature, meaning it readily attracts and absorbs water [35].
Figure 1.
Illustration of the cellulose life cycle, from its natural origin in plant cells to its end-use applications. Cellulose is synthesized in the plant cell wall as fibrils, which are assembled into microfibrils and polymer chains. After extraction, it can undergo structural and chemical modifications (including purification, surface activation, and functionalization) to enhance its properties for specific applications. Functionalized cellulose can be used in wound dressing, drug delivery, and biodegradable films. Following use, these materials can degrade in the environment, supporting a sustainable and circular bio-economy. Reproduced with permission from reference [36].
Bacterial Cellulose (BC) was first identified by A.J. Brown in 1886 during fermentation process research, when, on the media surface a thick gel was formed by Komagataeibacter xylinus bacteria [37]. Komagataeibacter xylinus is a member of the acetic acid bacteria, a group of Gram-negative aerobic bacteria that produce acetic acid during fermentation and also cellulose. Later in 2012, the species were reclassified under the newly established genus Komagataeibacter, becoming the type species of this genus [38]. Bacterial cellulose (BC) is a highly versatile natural polymer produced by such bacteria, but the high cost of fermentation mediums limits its widespread production. Practically, BC may grow as a solid film, or as dispersed fiber based on whether the culture is left undisturbed or stirred [39].
Although BC is chemically identical to plant cellulose, it has a distinct physical structure and is drastically involved in biofilm formation. Basically, it is composed by repeating β 1,4-D glucopyranose units, which are essentially glucose molecules linked by β 1,4-glycosidic bonds [40]. BC is also referred to as ‘nanocellulose’ and is generated during microbial metabolism, where β-1,4-glucan chains are polymerized from uridine diphosphate glucose (UDP-GLC) and are extruded to form microfibrils. Then these microfibrils recombine into bundles and ribbons and eventually form a porous, reticulated web-like structure [41].
BC is an exopolymer free from lignin and hemicelluloses thus represents the purest form of cellulose. As a result, it offers superior crystallinity, better mechanical strength and moisture absorption compared to plant based cellulose. Another BC’s great characteristic is the water holding capacity that can reach up to 1000% of its weight compared to 60% for plant cellulose, whereas different microorganisms can produce BC-like polymers with varying shapes, structures, and properties [42]. Additionally, it has a greater polymerization degree and smaller fiber diameter than plant cellulose and is characterized by high porosity, biodegradability, and large surface area. Even though BC has a chemical formula of (CH10O5)n, similar to plant cellulose, but with distinct chemical and physical properties as seen on Table 1.
Table 1.
Comparison of plant cellulose and bacterial cellulose properties.
All these properties make BC an exceptional biopolymer with significant advantages over plant-based cellulose, which has tremendous potential in many fields and applications [40,42]. On top of that, as is discussed in detail below, BC can be produced sustainably, from waste valorization schemes, highlighting its potential use in circular based approaches.
BC is produced as an extracellular polymer, which facilitates its extraction in high purity [43]. Its production depends mainly upon the medium nutrition components’ availability and especially on the availability of a carbon source. Despite many cultivation media and carbon sources have been screened and reported Hestrin–Schramm (HS) medium remains the most successful for BC production. Gluconacetobacter xylinus is the model organism for BC production at commercial levels. It is characterized by a high production capacity which is attributed to the multiple copies of BC synthesis genes in its genome [44]. Two of the usual methods for large-scale production of bacterial cellulose (BC) include (a) static fermentation: In this case, BC is developed at the air-liquid interface (the area where air touches the liquid culture). Because of the oxygen demand of formsroducing bacteria (aerobic nature), the cellulose form a film or sheet-like structure known as pellicles at the surface and (b) agitated fermentation: Under agitated conditions, i.e., if the culture is being stirred or shaken BC does not grow as a sheet. Rather, it grows in the form of randomly placed pellets or suspended fibers in the liquid medium [45] (Figure 2). Different BC morphology has been observed following static and agitated fermentation [46]. Thus, BC applications are dependent on the type of fermentation, as well as the physical and mechanical features of the formed BC, although both processes have advantages and disadvantages.
Figure 2.
Schematic representation of the purification process of bacterial cellolose produced static and agitated fermentation conditions. Under static conditions (left), BC is formed as a pellicle at the air–liquid interface and is manually collected. Under agitated conditions (right), BC is produced in the form of dispersed spherical pellets, which are harvested via centrifugation. Both forms undergo multiple washing steps with distilled water to remove residual medium and loosely bound bacterial cells. This is followed by an alkaline treatment using 0.5% NaOH at 80 °C for 30 min to eliminate any remaining bacterial cells and impurities. Subsequently, the samples are washed repeatedly with distilled water until a neutral pH is achieved. The final purified products are either BC pellicles or BC pellets, depending on the initial cultivation method. Reproduced with permission from reference [45].
As mentioned above, the Hestrin–Schramm medium is the most used for BC cultivation. It is composed of D-glucose, peptone, yeast extract, sodium phosphate dibasic, and citric acid [47]. Based on this composition, modifications have been investigated that vary the carbon source, i.e., fructose, sucrose, glycerol, mannitol, etc. [48]. However, the use of commercial nutrient sources is not economically viable since their production cost is high, which limits the BC industrial scale production and, as a result, its applications. For this reason, cost-effective carbon feedstocks such as by-products and residues from different industrial sectors can be used to reduce a significant source of pollution [9] coming from various types of agro-waste. If these streams are rich in carbohydrates, protein, nitrogen, or essential oils and fatty acids, they can be used for the production of bacterial cellulose and this utilization process contributes greatly to the circular economy and, to an extent, to the Sustainable Developmental Goals as well [49], [50], [51].
2.2. Categorization of Functionalization Methods and Applications of Interest for Cellulose and Bacterial Cellulose Membranes
The abundance of hydroxyl groups in BC offers numerous possibilities for modifications to improve its functionality. BC’s hydroxyl groups bound the water molecules tightly within the cellulose chains, leading to excellent water retention ability [52]. Moreover, the combination of the high surface area due to the high aspect ratio of the fibrils and the high porosity makes it a great candidate for physical antimicrobial interactions [53]. To conclude, besides the hydroxyl groups, BC is also rich in a variety of reactive groups that also can be modified in situ or ex situ to introduce functionalization for specific purposes [54].
Solid surfaces—specifically solid–liquid and solid–gas interfaces like those of bacterial cellulose (BC)—have complex structures and properties that depend on the nature of the solid, the preparation method, and interactions with the surrounding environment. Both the physical and chemical properties of these surfaces influence how they interact with other materials.
The demand for functionalized additive materials based on bacterial cellulose (BC) has experienced immense expansion, attributed to their versatile applications in various industries. Fabrication of BC-based additive materials typically involves two main strategies: in situ and ex situ modifications (Figure 3) [55].
Figure 3.
Illustration of the two main approaches for the modification of BC. (A) In situ modification and (B) ex situ modification. During in situ modification, additive materials are introduced directly into the culture medium either before or during the fermentation process. The pre-inoculum is transferred into culture medium containing the desired additives, and the microbial culture is incubated under appropriate production conditions. During BC biosynthesis, the additives become integrated within the growing cellulose matrix. In contrast, during ex situ modification: BC is first biosynthesized under standard conditions without additives. After harvesting and purification, the resulting BC is subjected to post-synthesis modification. This can involve direct immersion of purified BC into a solution containing the additive materials or the preparation of a BC slurry followed by casting with additives. This method allows greater control over the final composition and structure of the modified BC. Reproduced with permission from reference [55].
In situ modification involves the incorporation of additive materials, i.e., soluble or dispersed substances, in the BC production process. These substances must be nontoxic and must not inhibit bacterial cell growth. However, their addition may influence BC yield and self-assembly process. However, ex situ modification takes place after BC formation. More specifically, additive materials can be incorporated in their structure, or the BC membrane can be further processed to tune in demand to the surface morphology or the surface chemistry. In general, in situ functionalization of BC depends on the nature of the production conditions.
In contrast, ex situ modifications are realized after BC production, providing functional modulations and further expanding the applications of BC [55]. Such methods are lithography, etching, deposition, which have been utilized for producing superhydrophobic surfaces [56,57]. Recently, wetting control and superhydrophobicity has been linked with other functionalities, such as atmospheric water harvesting [58], phase change applications [59,60], antifogging [61], membrane distillation [4], and control of microorganisms (i.e., antibacterial, antifungal, etc.) [62] or other biomolecules [63]. Examples of both categories of functionalization for cellulose and bacterial cellulose will be presented in the following sections.
2.3. In Situ Functionalization Methods for Cellulose and Bacterial Cellulose Membranes
Bacterial cellulose (BC) is a valuable biomaterial with a fine fiber network, biocompatibility, high water retention, and strong mechanical properties. Still, its high crystallinity leads to poor rehydration after drying. In addition, it is mainly hydrophilic. To address these limitations, several methods for the morphology, as well as the surface chemistry modification, have been proposed. Below, we present the most popular and effective in situ methods for both structural and chemical functionalization of BC.
2.3.1. In Situ Chemical Functionalization Methods
In situ chemical functionalization methods for BC substrates mainly involve techniques which alter the bulk characteristics by biological and chemical methods. Thus, they drastically influence BC before its formation on a molecular level and as a result the physical and chemical characteristics of the synthesized biofilms.
Efforts to enhance bacterial cellulose (BC) production and its characteristics during fermentation have focused on optimizing growth conditions and fermentation parameters, including modifying the culture media, carbon and nitrogen sources, oxygen levels, and pH.
Chen H. et al. [64] introduced carboxymethylcellulose (CMC) into the BC culture medium, which altered BC formation in situ, producing a modified version called Carboxymethylcellulose-modified Bacterial Cellulose (CBC). CBC had weaker mechanical strength than BC, and a denser cellulose network. At a 1.0% CMC concentration, CBC had the lowest crystallinity and the highest rehydration ability. The reduced crystallinity contributed to more amorphous regions, improving water absorption during rehydration. This modification allows BC to be stored in a dry state, potentially extending its shelf life and expanding its applications.
Arooj Fatima et al. [65] studied bacterial cellulose membrane production using three bacterial strains: Komagataeibacter sp. FXV3, Komagataeibacter sp. NFXK3, and K. intermedius LMG 18909. The study aimed to explore the potential of bacterial cellulose for use in air/gas filtration. As shown in Figure 4i, the incorporation of ENCC (blue) or BNCC (pink) during the in situ modification of BC significantly influenced the distribution and retention of PLL. ENCC enhanced porosity and surface accessibility, resulting in greater PLL adsorption (purple), while BNCC led to increased amounts of unbound PLL (brown) due to steric hindrance. The strains produced varying amounts of cellulose, with strain NFXK3 yielding the highest cellulose production: 9.61 g/L with glucose and 11.46 g/L with glycerol. In contrast, strain LMG 18909 produced more cellulose from glucose (5.93 g/L), while FXV3 produced approximately 5 g/L, regardless of the carbon source. The study also found that the addition of ethanol to the growth medium enhanced bacterial cellulose production, with the highest ethanol concentration (3%) reducing membrane porosity and pore size. This change improved the suitability of the membranes for air and gas filtration applications. The bacterial cellulose membranes exhibited high crystallinity (71–85%), significantly higher than plant cellulose (40–60%). These membranes were also hydrophilic, swelling rapidly in water, and displayed mechanical properties enhanced by ethanol, with NFXK3 membranes being the strongest, comparable to synthetic polypropylene (30–40 MPa). Gas permeability tests revealed that membranes made from strain NFXK3 were less permeable due to their dense structure, while FXV3-based membranes exhibited higher gas permeance due to their more porous structure. The study concluded that bacterial cellulose membranes were effective for air filtration, capable of retaining particles larger than 0.2 µm, including bacteria, and potentially filtering viruses.
In another study, bacterial cellulose (BC) derived from Kombucha symbiotic culture of bacteria and yeast (SCOBY) was in situ functionalized by incorporating diatom frustules, silver nanoparticles (AgNPs), and poly(3,4-ethylenedioxythiophene): polystyrene sulfonate PEDOT: PSS) into the BC matrix. Diatom frustules enhance tensile strength and UV blocking capabilities, while AgNPs improve plasmonic activity and reveal potential for biosensing applications. Functionalized BC exhibits antimicrobial effects against Gram-positive and Gram-negative bacteria, and dual functionalization with AgNPs and PEDOT:PSS enhances electrical conductivity. The study highlights the efficiency and scalability of the bottom-up in situ synthesis approach, requiring minimal infrastructure while allowing controlled functionalization. The f-BC nanocomposite exhibits potential applications in the food, medical, packaging, and cosmetic industries, with further research needed to explore its full commercial viability [66].
In the study of Seyed Mohammad Amin Ojagh et al. [67], in situ modification of BC included its reinforcement with highly functional cellulosic nanomaterials (HNCC) that contained enzyme-treated (ENCC), bacterial-treated (BNCC), and synthetic-treated (SNCC) varieties (Figure 4ii). The inclusion led to the incorporation of new functional groups to BC, promoting a significant enhancement in its physicochemical nature. This modification led to an increased swelling ratio, lowered crystallinity index (CI), and improved mechanical strength compared to pure BC. Also, HNCC addition altered the pore sizes of the nanocomposites and thereby rendered them more suitable for applications like solid–liquid phase filtration. The BC/HNCC composites also exhibited enhanced biological properties. The nanocomposites had an increased loading capacity of PLL (Poly-L-lysine), a natural antibacterial agent, with BC/ENCC exhibiting the maximum PLL loading (~327 mg g−1) in comparison to BC by itself (~66 mg g−1). The composites exhibited excellent efficiency against Gram-negative and Gram-positive bacteria and good biocompatibility, and no cytotoxicity was observed in human bone marrow stem cells (hBMSC). As a conclusion, these modifications upheld the prospects of in situ functionalized BC/HNCC nanocomposites for a range of biomedical and environmental uses such as wound dressing, targeted drug delivery, and filtration.
Ogrizek et al. [68] produced all-cellulose biocomposites by cultivating BC in situ on cotton fabric. The cotton fabric was modified using low-pressure oxygen plasma in afterglow, E-mode, or H-mode. Biocomposites were formed by placing the treated fabric in a BC culture medium and incubating for seven days. Oxygen plasma afterglow introduced additional polar functional groups, while H-mode modification also caused etching and surface roughening, enhancing adhesion and increasing deformation capacity. In contrast, extended E-mode treatment led to excessive etching and the defibrillation of the fibers.
On the study of Wu et al. [69] the surface of the nanocellulose was modified in situ in an aqueous medium of coniferin. This method mimics the lignification process in plant cell walls in a creative way for the surface functionalization of nanocellulose. Unlike conventional practice in synthesizing dehydrogenation polymers (DHPs) of lignin from an aqueous medium, coniferin was utilized. DHPs were prepared via peroxidase-catalyzed polymerization and deposited on the nanocellulose surface. The DHP-crosslinked nanocellulose was then processed into membranes, where the content of DHP enhanced the water contact angle and hydrophobicity significantly even at low DHP quantity.

Figure 4.
(i) In situ modification of bacterial cellulose (BC) with poly-L-lysine (PLL) in the presence of enzymatically modified (ENCC, blue) or hairy (BNCC, pink) nanocellulose. ENCC promotes higher PLL binding (purple), while BNCC leads to more unbound PLL (brown) due to steric hindrance. The adsorption kinetics plot shows greater PLL uptake (Γₑ) in BC/ENCC (blue points) than in BC/BNCC (pink) and unmodified BC (black), reflecting the effect of porosity on binding efficiency. The different biosynthesis methods followed to produce BC with different porosity, which is intended to be used for air filtration applications. Reproduced with permission from reference [65]. (ii) (Top) In situ modification of BC with highly functional cellulosic nanomaterials (HNCC) that contained enzyme-treated (ENCC), bacterial-treated (BNCC), and synthetic-treated (SNCC) varieties. (Down) Kinetics of PLL adsorption by BC/CNC, BC/ENCC, and BC/BNCC nanocomposites based on bound PLL. Reproduced with permission from reference [67]. (iii) SEM images and actual images of the chitosan (CS)/foaming bacterial cellulose (FBC) samples using different percentage of chitosan. (a) FBC, (b) 0.5% CS/FBC (c) 1% CS/FBC, (d) 1.5% CS/FBC, (e) 2% CS/FBC and (f) 2.5% CS/FBC. Reproduced with permission from reference [70].
In the study of Lin et al. [70], researchers developed a novel antimicrobial packaging material composed of bacterial cellulose (BC) and chitosan (CS)-a natural polysaccharide-, as a sustainable alternative to conventional petroleum-based packaging materials (Figure 4iii). This functional material foaming BC with chitosan (CS/FBC) exhibited high water absorption, excellent mechanical properties, and significant effects on bacterial growth against Escherichia coli and Staphylococcus aureus. When applied to chilled sea bass, CS/FBC effectively delayed spoilage by inhibiting the growth of Shewanella putrefaciens, reducing total volatile basic nitrogen (TVBN) release, and slightly preventing lipid oxidation. Additionally, its high swelling capacity allowed it to absorb excess liquids from food products, such as blood from meat, while serving as a matrix for antimicrobial or antioxidant agents. If the production of this material could be scaled, it would hold great potential as an active packaging solution to enhance food preservation.
Cai and Kim et al. [71] developed BC/gelatin composite scaffolds by combining aqueous gelatin solution with BC produced by Acetobacter xylinum. The morphology of the BC/gelatin scaffolds showed that gelatin molecules successfully penetrated the spaces between the BC nanofibers. The addition of gelatin to BC led to a decrease in the crystallinity index but improved the thermal stability of the composite. Swelling tests showed that the composite absorbed less water compared to pure BC, with the water uptake capacity being half that of BC alone. Interestingly, the cell adhesion studies using 3T3 fibroblast cells indicated that the BC/gelatin scaffolds supported cell attachment and proliferation after 48 h of incubation, demonstrating superior biocompatibility compared to pure BC. This suggests that the BC/gelatin scaffolds are bioactive and suitable for applications such as wound dressings or tissue engineering scaffolds.
The research team of Maryana Melo Frota et al. [72] developed an eco-friendly superhydrophobic coating for food packaging by functionalizing bacterial cellulose nanofibrils with food-grade silicon dioxide (SiO2) nanoparticles. The nanofibrils were sourced from SCOBY, a by-product of fermented beverages and were incorporated into a beeswax matrix to create a composite coating (BW/BCn-SiO2) that demonstrated outstanding water-repellent properties, achieving a contact angle of 153° and a slip angle of 3°, consistent with Cassie–Baxter model superhydrophobicity. The coating also exhibited strong mechanical and environmental durability, retaining superhydrophobicity after cold storage, pH variation, and mechanical stress. Notably, it maintained its superhydrophobicity after abrasion testing, where the surface was rubbed 10 times with 240-grit sandpaper under a 200 g weight, simulating mechanical stress conditions, and still exhibited a high contact angle of 155.3°. The coating effectively repelled various viscous foods, such as honey and chocolate sauce, highlighting its potential to minimize food residue and packaging waste. Toxicity assays using Artemia salina showed low toxicity at concentrations up to 100 μg/mL, confirming its safety for food contact applications.
Finally, extending the concept of BC functionalization to the field of smart textiles, Li et al. [73] developed a photochromic bacterial cellulose (PBC) platform with multicolor switching and UV-sensing capabilities. Using a green in situ biofermentation approach, photochromic dyes were embedded directly into the growing BC nanonetwork, achieving uniform distribution, strong dye-substrate bonding, and enhanced fastness. Under UV exposure (365 nm), the films rapidly discolored within 1 min and fully recovered their original coloration under visible light in under 2 min. This switching behavior remained consistent over 30 irradiation cycles. The films retained their mechanical flexibility and function after bending, twisting, 30 abrasion cycles (under 500 g load), and 5 standardized washing cycles, highlighting their wearability and durability. Based on tunable dye concentrations, the researchers also fabricated a multicolor PBC system (red, yellow, blue, green, purple), which supported high-resolution photopatterning (QR codes, logos) and UV exposure warning in wearable applications. This strategy not only broadens the application scope of BC materials but also enables scalable, eco-friendly production of photoresponsive textiles for daily use and skin protection.
2.3.2. In Situ, Pattern Transfer Methods
In situ pattern transfer methods a mold with a specific geometry is placed inside the cultivation container to produce a highly accurate negative replica of the mold (Figure 5i) [74]. Abol-Fotouh et al. [75] combined polydimethylsiloxane and agarose gels in order to shape in situ BC. This approach enabled 3D shaping by growing bacterial cellulose (BC) within a viscoelastic agarose gel, cast inside polydimethylsiloxane (PDMS) molds that replicated the target implant geometry. In the first method, a PDMS mold shaped like a doll’s ear was used to produce an exact BC replica. In the second method, a PDMS mold of a doll’s face was combined with alternating exposure to and shielding from aerial oxygen during BC production. Remarkably, the resulting BC face clone fitted perfectly to the original doll face template, and its mechanical properties were comparable to those of collagen. (Figure 5ii). Importantly, the ability to guide BC growth into specific micro- and nano-patterns offers a route to surface functionality for biomedical applications.

Figure 5.
(i) Guided assembly-based biolithography (GAB) proposed by Bottan et al. A cyclic olefin copolymer (COC) substrate is used to fabricate a surface-patterned PDMS mold via soft lithography. This PDMS mold is then placed at the interface of the bacterial growth medium during fermentation, guiding the upward assembly of surface-structured bacterial cellulose (S-BC). Reproduced with permission from reference [74] (ii) (A) Schematic representation of the method used to produce bacterial cellulose. (B) Image demonstrating that the cellular kinetics are reversed by using an O2 impermeable seal and the formed basal BC film is biolithographed by the PDMS base. (C) Image depicting the concept of creating a doll ear Reproduced with permission from reference [75]. (iii) The patterns created using biolithography with PDMS molds, resulting in structured BC films. (A) The PDMS mold as well as the BC film after removing it from the mold are presented. SEM images of the different micro-structures created on the BC film are presented in (B–F). These microstructured surfaces have potential applications in biomedical devices, microfluidics, and tissue engineering due to their enhanced surface control and functional properties. Reproduced with permission from reference [76].
Roig-Sanchez et al. [76] also tried the biolithography process for producing structured bacterial cellulose (S-BC) films involved preparing a liquid medium for bacterial growth, which consisted of yeast, peptone, citric acid, disodium hydrogen phosphate, and dextrose. After autoclaving the solutions, they were mixed under sterile conditions. Bacteria were grown in stages: first, expanded into fresh medium for 7 days at 30 °C, then transferred to a new medium for an additional 3 days. A 1:14 inoculum-to-medium ratio was used, and PDMS molds were placed on top of the liquid culture to guide the growth of patterned BC films. After 3 days of incubation, the PDMS mold was removed, and the S-BC films were harvested, cleaned, and treated with ethanol, boiling water, and NaOH to remove impurities. The PDMS mold, which was used to guide the growth of the BC film, managed to produce wet-patterned films. These films can withstand OD and SCD, maintain the structure even after 5 h rehydration and could be ideal to design microfluidic devices in a single step. For that, a proof-of-concept of their channel diffusion was tested showing capillarity (Figure 5iii).
2.4. Εx-Situ Functionalization Methods for Bacterial Cellulose and Cellulose
Ex situ modification refers to post-synthesis modification of bacterial cellulose, in which physical, chemical, or biological treatments are applied to enhance or modify its properties without interfering with the BC production process. Such methods allow more control over structural and functional modifications than in situ techniques. Some of the common ex situ modifications are chemical functionalization, polymer grafting, nanoparticle impregnation, and enzymatic treatment. These techniques can broaden the applications of BC by adding novel properties like conductivity, antimicrobial activity, enhanced mechanical flexibility and wetting properties control. The motivation for converting BC into a superhydrophobic material lies primarily in the use of BC in applications which require wetting control. Examples include antibacterial as well as separation applications, in which superhydrophobicity can play a crucial role. For example, reducing bacterial adhesion and biofilm formation by creating surfaces that repel aqueous-based microbial environments. This passive antimicrobial strategy is also valuable in applications such as wound dressings, packaging, or coatings, as will be presented in Section 3. Moreover, BC is an ideal candidate for surface functionalization due to its porous nanofibrillar structure and high surface area. By modifying its surface to achieve superhydrophobicity, we not only preserve its biocompatibility and mechanical integrity, but also introduce additional functionality relevant to separation applications, in which currently only synthetic polymers are used.
2.4.1. Ex Situ, Chemical Modification and Synthesis Methods
One example of ex situ, chemical surface functionalization of BC membranes is the work of Bryszewska et al. [77], which aimed to modify bacterial cellulose (BC) to increase its resistance to moisture and enhance its hydrophobicity. BC is naturally hydrophilic, which limits its use in certain applications. To address this limitation and expand its range of applications, the conversion of BC to a superhydrophobic material can provide moisture resistance, self-cleaning behavior, and enhanced performance in separation applications. In the first example, BC was modified with apple powder (AP) and stearic acid to produce hydrophobic materials (Figure 6i). The samples were coded as follows: A0 represents BC modified with glycerol only, A40 refers to BC modified with glycerol followed by another treatment (such as apple powder or other agents), A0[S10] refers to BC modified with glycerol and treated with a mixture of HSt at a concentration of 10%, and A0[S10.A60] refers to BC modified with glycerol, treated with HSt at 10%, and apple powder at 60%. FTIR and modeling theory showed that the modifications decreased the interactions of cellulose with water, rendering the material more hydrophobic. The contact angle of the material to water rose from 38° to 125°, confirming the heightened hydrophobic nature. This transformation is crucial for enabling BC-based materials to function effectively in applications that require water resistance and non-wettability (i.e., separation applications). However, no materials exhibited antimicrobial activity against the tested microorganisms. The work was able to produce BC materials with enhanced resistance to moisture, which shows potential for application where hydrophobicity is needed; however, the exploration of antimicrobial activity can be addressed in future studies.

Figure 6.
(i) Evaluation of wettability and surface properties of bacterial cellulose (BC) following surface modification with apple powder (AP) and stearic acid (St). Measurements include water and diiodomethane contact angles, polar and dispersive components of surface free energy, total surface free energy, and surface roughness. The incorporation of stearic acid and AP significantly increased the water contact angle, demonstrating successful hydrophobization. Adapted with permission from reference [77]. (ii) Contact angle characterization of BC films functionalized with different chemical groups: vinyl (Vinyl-M), perfluoroalkyl (Fluori-M), thiol (Thiol-M), and amino (Amino-M). (a) Water contact angle measurements of various functionalized BC surfaces. (b) Time-dependent stability of the water contact angle for Vinyl-M. (c) Wettability evolution over time for Fluori-M and Amino-M. Functionalization with fluorinated moieties resulted in durable hydrophobicity. Reproduced with permission from reference [78]. (iii) Scanning electron microscopy (SEM) images showing the surface and cross-sectional morphology of pristine BC, oxidized BC (oxBC), and composites of BC or oxBC with collagen (Col) and tannic acid-based crosslinkers (TGₐₘ and TGₛ). Variations in structure and fiber organization at different magnifications highlight the effects of oxidation and composite formation on BC microstructure. Reproduced with permission from reference [79].
Another study presents a straightforward and effective strategy to functionalize cellulose membranes (CMs) through salinization and thiol–ene chemistry procedures to tune their properties for water purification applications. Three different groups, perfluoroalkyl (Fluori-M), thiol (Thiol-M), and amino (Quater-M), were used in the functionalization process, which provided different functionalities [78] (Figure 6ii). The Fluori-M membranes were superhydrophobic (water contact angle 154°) and successfully separated water-in-oil emulsions. Thiol-M membranes had good Pb2+ adsorption, and the membranes can be utilized for heavy metal elimination. The Quater-M membranes, quaternate with benzyl bromide, had excellent antibacterial activity against E. coli and S. aureus. The technique was both effective and responsive with good functionalization achieved within minutes. Economic consideration suggested that reagent and solvent costs (primarily DCM and PFDT) could be minimized to make it more viable. This process offers a potentially viable technique for future CM applications such as oil–water separation, heavy metal remediation, and antimicrobial activity.
In another study, Sommer et al. [79] prepared bacterial cellulose/fish collagen composites (BC/Col) by enzymatic and chemical cross-linking ex situ. Collagen is the major structure protein of organisms and works as an excellent barrier against oxidation. Two transglutaminases were used for the enzymatic cross linking (TGWM, TGGS) and a peroxidized one for the chemical one (oxBC). The results showed that BC/Col composites cross-linked through enzymatic reactions are more effective compared to the cross-linking through chemical reactions, depending on the enzyme used and offer greater degree of crystallinity and thermal stability (Figure 6iii).
According to Barud et al., nanocomposites [80] were prepared from BC and SF, which are both natural biopolymers commonly used in tissue engineering and biomedical applications. The in vitro tests indicated that the material was neither cytotoxic nor genotoxic. SEM images showed that more cells adhered to the BC/SF: 50% scaffold surface compared to the pure BC scaffold, suggesting that the addition of fibroin enhanced cell attachment. This effect may be attributed to the amino acid sequence of SF, which functions as cell receptors to promote cell adhesion and growth. As a result, BC/SF:50% scaffolds are a promising option for bioengineering, with potential applications in tissue regeneration and cell cultivation on.
Another way for the wet modification of bacterial cellulose (BC) is by oxidizing it with sodium periodate to introduce aldehyde groups, creating dialdehyde bacterial cellulose (DBC) [81]. This was then chemically crosslinked with quaternized chitosan (QCS) via Schiff base reactions, forming a composite hydrogel (DBC/QCS). This modification allowed the hydrogel to retain its structure and rehydrate after drying, overcoming a major limitation of traditional BC hydrogels. The resulting material exhibited exceptional swelling behavior (over 1000%), strong antibacterial activity (over 80% kill rate against E. coli and S. aureus), and improved mechanical strength. Furthermore, when loaded with pirfenidone (PFD), it promoted wound healing and reduced scarring in rat models.
It is therefore evident that several examples of BC-based composites exist in the literature, including BC/chitosan, BC/agarose, BC/poly(3-hydroxybutyrate) (PHB), BC/hydroxyapatite, and BC/collagen, which have been commercialized and are considered non-genotoxic and non-cytotoxic. Among the materials studied for BC composites, silk fibroin (SF) has been chosen due to its potential in biomedical applications. Silk fibroin, derived from the silk of Bombyx mori silkworms, can be processed into a variety of materials, including hydrogels, films, and fibers. It offers attractive properties such as biocompatibility, oxygen and water vapor permeability, and biodegradability, which can be further enhanced through functionalization or altering processing methods [82].
2.4.2. Plasma Based Functionalization Methods
Plasma treatment is an eco-friendly alternative to traditional methods, which can be used for cellulose surface modification and functionalization, as it produces no solid and liquid waste. Plasma treatment allows modifying the surface with high precision without influencing the inherent properties of the polymers. This is particularly valuable for converting naturally hydrophilic biopolymers like cellulose into hydrophobic or even superhydrophobic materials, which broadens their usability in applications requiring water repellency, such as protective coatings, packaging, separation, and biomedical devices. Moreover, the reactive environment formed, which consists of electrons, ions, atoms, free radicals, and excited molecules, enable surface morphology and chemistry processing without the need for toxic catalysts or solvents and is a fast and green modification process [4,83,84].
This approach overcomes the drawbacks of conventional chemical modification techniques that are typically contaminating, tedious, and time-consuming [85,86]. When plasma interacts with the surface of polymer substrates, it can result in several effects such as (i) etching or cleaning of the surface, (ii) the introduction of functional groups, (iii) the creation of a coating layer via plasma polymerization of a precursor, and (iv) graft polymerization. During plasma etching and functionalization, the selection of inert or reactive gases is a very significant parameter which affects the amount and type of surface functional groups formed on the polymer surface [87].
Rolim et al. [88] studied the properties of bacterial cellulose produced from kombucha and treated with low-pressure cold plasma. The impact of various factors, including the gas mixture (Ar/acetylene and Ar/acetylene/H2), treatment time, and duty cycle, was assessed.
A plasma deposition method was used to modify bacterial cellulose (BC) by introducing oxygen-containing functional groups and incorporating silver nanoparticles (Ag NPs) for antimicrobial properties. The plasma treatment was conducted in a gas-discharge glass chamber under vacuum conditions (10 Pa), with a high-voltage discharge frequency of 15 ± 5 kHz, a source voltage of 3 kV, and a generator power of 100 W. BC samples were exposed to oxidizing plasma for 1, 3, and 5 min, which helped activate the surface for better nanoparticle adhesion. To deposit Ag NPs, DC magnetron sputtering was performed using a 99.99% pure silver target (10 cm diameter). The BC samples were placed 40 mm from the target, and argon (99.99%) was used as the bombardment gas. Before deposition, the system was degassed to a vacuum of 5.0 × 10−4 Pa. Silver was then deposited at a pressure of 0.2 Pa, voltage of 700 V, and power of 400 W for 60 s. This process ensured a stable and uniform Ag NP coating on the BC surface, enhancing its antimicrobial effectiveness against bacteria and fungi [89].
In another study, plasma treatment was applied to bacterial cellulose (BC) membranes to enhance cell adhesion [90]. The results were analyzed using CA measurements, XPS, and SEM. While the treatment did not improve wettability, it significantly increased surface porosity and introduced nitrogen-containing functional groups. Cell adhesion and proliferation studies through MTS assays revealed that the treated BC (BCP) significantly improved the attachment of microvascular (HMEC-1) and neuroblast (N1E-115) cells but had little effect on fibroblast (3T3) cells.
In their study, Janpetch et al. [91] utilized bacterial cellulose (BC) as a template for ZnO deposition via a plasma solution process. The resulting ZnO/BC composites exhibited strong antibacterial activity, making them suitable for antibacterial applications against E. coli and S. aureus. In this case, the hydrophobic nature induced by plasma treatment played a synergistic role alongside the antimicrobial functionality of ZnO, making the BC-ZnO composites more effective in moist environments. The results showed that the ZnO synthesized on BC nanofibers have a different morphology when compared to ZnO synthesized without BC as a supporting material.
Additionally, Leal et al. [92] used the combination of oxygen plasma deposition and silanization with trichloromethyl silane (TCMS), for the BC surface treatment. After the plasma treatment, the roughened BC films were silanizated inside a reduced pressure chamber by TCMS reagent. Apart from the SEM images regarding the surface and the internal structure of the BC membranes, optical profilometry was also evaluated and the results are positive to the observation by using SEM. Specifically, the non-treated and Sil-treated BC membranes present a similar and smoother roughness profile in comparison to the PlasSil (Plasma-Silinazation) samples. PlasSil membranes showed a high variation in thickness throughout the analyzed area, which indicates a high roughness and a higher surface area.
In another work, bacterial cellulose which was produced in an oxygen-rich, liquid environment with kombucha as the culture medium was plasma treated using a cathodic cage plasma system, where the sample is placed inside the cage, and the plasma glow discharge occurs outside [93]. The gas mixture used (C2H2/H2/Ar) generates reactive species, with acetylene acting as both a product and precursor for plasma polymerization. This method is environmentally friendly and safe, producing low material content and reducing hazards. Plasma polymerization involves complex reactions and ion fragmentation, leading to the deposition of a polymer film on the substrate’s surface. The untreated bacterial cellulose had a contact angle of 33.4°, indicating its hydrophilic nature. Plasma-treated bacterial cellulose, however, showed an increase in contact angle, by altering the surface roughness and chemical composition, which lowers the surface energy. Plasma treatments generated a thin polymer film that decreased the free surface energy, resulting in increased contact angles, some approaching 100° which indicate hydrophobicity.
Matouk et al. [94] presented a new non-thermal plasma approach to surface-modify cellulose nanocrystals (CNCs) for wetting control (Figure 7i). Treatment of CNCs with three plasmas, Ar/CH4, Ar/SiH4, and Ar/CH4-SiH4, in a cylindrical DBD reactor, led to increased hydrophobicity without sacrificing the crystalline nature of CNCs. XPS analysis revealed that Ar/CH4 treatment creates CHx groups, whereas silane-based treatments create hydrophobic species through reaction with adsorbed water on the surface. The plasma technique presents a viable means of adjusting the wettability of CNCs without changing their intrinsic properties.
Figure 7.
(i) Schematic representation of the surface modification of cellulose nanocrystals (CNCs) via a non-thermal cold plasma process using different gas compositions (Ar/NH3, Ar/CH4, Ar/SiH4) to tailor surface wettability. Water contact angle measurements before and after treatment reveal tunable surface properties, ranging from hydrophilic (18° ± 2°) to superhydrophobic (150° ± 2°) depending on the plasma gas used. Reproduced with permission from reference [94]. (ii) Conceptual diagram and experimental demonstration of the fabrication of multifunctional, biodegradable packaging materials. Starting from eucalyptus pulp, regenerated cellulose (RC) films are prepared and subsequently coated with silicon oxide (SiOx) using plasma-enhanced chemical vapor deposition (PECVD). The resulting SiOx/RC composites exhibit enhanced barrier properties, flexibility, waterproofing, and environmental sustainability. Real-life packaging tests confirm long-term protection performance. Reproduced with permission from reference [95].
Yangfan Xu’s et al. [95] presented a plasma-enhanced chemical vapor deposition method (PECVD), which enabled the deposition of a dense SiOx coating on cellulose films. (Figure 7ii). The findings demonstrated a remarkable improvement of the water vapor and oxygen barrier performance of the composite film, which was close to the performance level of market-available barrier films. It further exhibited superior mechanical strength, hydrophobicity, and freshness preservation, rendering it a promising candidate for bio-derived high-barrier packaging materials. Initially, argon (Ar) was employed as a pre-treatment gas to purify and ionize the surface of the Aa-RCF substrate for 60 s, which provided favorable conditions for the upcoming coating process. Afterwards, a SiOx layer was deposited with the activation of O2 as an oxidizing agent and HMDSO as the source of silicon.
Another research study by Babaei et al. [96] illustrates the application of plasma deposition techniques to augment the hydrophobic nature of cellulose nanocrystals (CNCs) without altering their inherent properties. With the assistance of a dielectric barrier discharge (DBD) reactor, CNCs were exposed to argon-based plasmas with methane (CH4) and silane (SiH4), resulting in the development of CHx and SiHx functional groups on their surfaces. These modifications greatly enhanced water repellency, with the highest hydrophobicity being observed for samples exposed to SiH4 and CH4-SiH4 plasmas.
According to Bhanthumnavin et al. [97], bacterial cellulose (BC) membranes were modified via oxygen plasma treatment, which significantly altered their surface characteristics and enhanced their performance in filtration applications. The membranes, produced by Acetobacter xylinum with and without coconut juice supplementation, were treated under different plasma conditions. Pressures of 0.1, 0.5, and 1.0 Torr, power at 300 W, and exposure times of 60 and 180 s. FTIR analysis revealed an increase in hydroxyl groups, particularly with enhanced peaks at 713 cm−1 and 3340 cm−1, indicating greater hydrophilicity. Correspondingly, the water contact angle decreased from 35° (untreated) to as low as 26° after treatment. Despite the increase in surface polarity, water flux dropped from 8.6 × 10−12 to ~3.2 × 10−12 m3·N−1·s−1, suggesting a 30% reduction in permeability.
In a study by Kirdponpattara et al. [98], a special sponge made from bacterial cellulose and alginate (BCA) to support yeast cells during ethanol fermentation was presented. To make the sponge water-attracting (hydrophilic), they treated it with oxygen plasma. This treatment made the outer surface rougher, which reduced the water contact angle, meaning water spread more easily. However, the treatment did not create enough hydrophilic groups inside the sponge’s pores, where yeast cells attach during fermentation. As a result, the treated and untreated sponges performed similarly in ethanol production, as they absorbed water and ethanol in the same way. The complex structure of the BCA sponge likely prevented oxygen from bonding deeply with it.
In a study by Orlando et al. [99], fabric was initially fabricated using the aqua-jet/spunlace-forming process, resulting in a highly porous and flexible structure, and subsequently coated with copper particles via plasma-based magnetron sputtering. This method facilitated uniform particle distribution across the surface without necessitating additional coatings, while preserving air permeability. Physicochemical characterization involved the quantitative analysis of copper content, microscopic evaluation through scanning electron microscopy (SEM), energy dispersive spectroscopy (EDS), and porosity measurements. Furthermore, hematological assays, including activated partial thromboplastin time (aPTT) and prothrombin time (PT), demonstrated that copper modification did not induce significant alterations in blood coagulation parameters, thereby confirming the material’s biocompatibility. The findings validate magnetron sputtering as an effective technique for copper deposition onto nonwoven cellulose fabrics, preserving their structural and functional properties. The resulting antibacterial and biodegradable composites exhibit significant potential for wound dressings and medical textiles, offering an environmentally sustainable and biologically safe alternative. Future research should focus on further optimization of these materials and expanding their biomedical applications.
Overall, plasma-based functionalization enables the transition of cellulose-based materials from a hydrophilic to a hydrophobic or superhydrophobic state without compromising their structural integrity. This is essential for expanding their usage in fields such as packaging, antifouling surfaces, wound dressings, and water-resistant textiles that can be used in desalination or other separation applications.
2.4.3. Electrospinning
In the work by M. F. Yazdanbakhsh et al. [100], wheat bran-based α-cellulose nanofibers were prepared by electrospinning of TFA/MC (Trifluoroacetic acid/methylene chloride) solutions. The flow rate was controlled in the range of 0.5–10 mL/min by using the micropump. Voltages in the range 12–30 kV were used. The cellulose disk created had higher absorption capacity of the antibiotic solution compared to a typical paper disk. The reason for this is the existence of large and regular pores in the cellulose morphology enabling increased absorbing and releasing of the antibiotic substance.
Ahmad Hivechi et al. [101] demonstrated an efficient approach using two-axial electrospinning method to fabricate and characterize hybrid nanofibers by in situ gelling oxidized carboxymethyl cellulose (OCMC)/gelatin nanofibers. The intended application was wound healing and the prepared nanofibers exhibited good antibacterial properties and biocompatibility. In addition, it was shown that the nanofibers could easily transform into a hydrogel when they were applied in a wound in a a moist environment, which is ideal for such applications (Figure 8i).

Figure 8.
(i) SEM images of the functional OCMC/PVA fibers after electrospinning using different concentrations from the two materials used. Reproduced with permission from [101]. (ii) SEM images of PLA/Gel nanofiber mats covered with 1, 3, and 5 wt% QACNC. QACNC was formed through condensation reactions between the quaternary ammonium salt and hydroxyl groups on the surface of CNC. Reproduced with permission from reference [102].
Moreover, a great application of electrospinning was demonstrated in the study by Maryam Madani et al. [102], in which PLA/Gel nanofiber surfaces with a high-surface-area morphology, enhancing the coating efficiency of QACNCs, were used. Compared to simple blending, the coating process resulted in improved and reproducible antibacterial activity, effectively inhibiting bacterial growth (Figure 8ii). Electrospinning was crucial in the fabrication of PLA/CNC composite scaffolds at the work of Dinesh K. Patel et al. [103], in which again the high-surface-area nanofibrous architecture was necessitated by tissue engineering. Electrospinning facilitated the production of dense and uniform nanofibers, whose diameter decreased with increasing CNC content, leading to enhanced mechanical and thermal properties. Nanofiber morphology significantly influenced biocompatibility, with improved cell viability, increased mineralization, and increased osteogenic gene expression. Consequently, the electrospun scaffolds possessed higher bone regeneration capability, rendering them highly sought-after biomaterials for bone tissue engineering.
2.4.4. Other Ex Situ Functionalization Methods
The dip coating method is widely used to create superhydrophobic surfaces, involving the immersion of a substrate into a coating solution, followed by drying and curing. The solution typically contains aqueous dispersions of nanoparticles like TiO2, SiO2, and ZnO, which help form a rough, low-surface-energy layer, but also other nanoparticles can be used in case of composite scaffolds. This method has led to the development of bacterial cellulose surfaces with enhanced chemical and mechanical durability, as the particle coatings strongly adhere to the substrate [104]. A very interesting method for deposition approach was conducted on the study of Mira-Cuenca et al. [105], in which screen-printing was used to deposit a dense solution of blended BC fibers with length of 14 ± 9 μm on previously coated with inorganic NPs SPIONs using a microwave-assisted method (Figure 9).
Figure 9.
Spatial and selective patterning of bacterial cellulose (BC) films with inorganic nanoparticles (NPs). Nanoparticles were selectively deposited onto partially dried BC films using stencil masks to confine their localization: (a) SPION-loaded BC fibers (BCf–SPIONs) were applied to one side of the film. (b) BCf–SPIONs were sandwiched between two BC films, partially isolating the nanoparticles (bottom row). (c) Films were surface-functionalized with either SPIONs (top row) or gold nanoparticles (Au NPs, bottom row). Reproduced with permission from reference [105].
The research team of Zong-Lin Li et al. [106] developed a novel SiO2-decorated bacterial cellulose (BC) “meta-skin”, combining superhydrophobic performance with precise ultrasonic functionality. To address the intrinsic hydrophilicity and poor mechanical stability of native BC in water, the team employed an ethanol-assisted ultrasonic dispersion method to uniformly integrate polydimethylsiloxane-treated SiO2 nanoparticles into a BC alcogel, resulting in a stable superhydrophobicity with a contact angle up to 170.2°. The resulting ultrathin (20 μm), ultralight (7.6 mg/cm2) material remained superhydrophobic even after 200 days in water and could undergo self-healing via Gluconacetobacter xylinus fermentation. This decorated BC meta-skin was successfully laser-cut into two functional ultrasonic metasurfaces: a holographic meta-lens (4 × 4 cm2, 18.6 mg, 20 μm thick) for acoustic holography at 500 kHz, and a 3D imaging meta-lens (24 mm diameter, 10.3 mg) for high-resolution ultrasound imaging at 5 MHz. The meta-lens achieved a reflectivity of 98.2%, enabled by the air-filled Cassie–Baxter nanostructures. The study demonstrates a new class of biodegradable, self-healing, and laser-processable acoustic metamaterials, advancing bio-integrated ultrasound applications in diagnostics and imaging.
Another study by Bhumin Than-ardna et al. [107] developed superhydrophilic bacterial cellulose (BC) membranes from nata de coco waste, modified with SiO2 nanoparticles via a sol–gel process (TEOS hydrolysis/condensation in ethanol and ammonia). The optimized membrane (BC-SiO2-7) exhibited a water contact angle close to 0° and underwater oil contact angles (UWOCA) > 126°, confirming excellent superhydrophilicity and underwater oleophobicity. The membranes had small pore sizes (0.12–0.17 μm) and enhanced surface roughness (Ra = 226.3 nm). These membranes achieved oil-in-water emulsion separation efficiencies up to 99% and water fluxes ranging from 142 ± 39 to 195 ± 24 L·m−2·h−1·MPa−1. Reusability tests showed stable separation performance (~96% efficiency after 5 cycles) and good antifouling behavior, with a flux recovery rate (FRR) > 85%, reversible fouling ratio (Rr) > 85%, and irreversible fouling ratio (Rir) < 15%. The membranes remained stable under acidic (pH 1), basic (pH 12), and saline conditions, demonstrating strong potential for eco-friendly wastewater treatment.
In a related effort, Taniyama et al. [108] developed cellulose nanocrystal (CNC) films functionalized with glycidyloxypropylsilane derivatives via a spin-coating process, aiming to control surface structure and introduce chemically active glycidyl groups. Two silanes—GPMDES (diethoxy(3-glycidyloxypropyl)(methyl)silane, containing both a reactive glycidyl group and a hydrophobic methyl group) and GPTES (triethoxy(3-glycidyloxypropyl)silane, containing glycidyl groups only)—were combined with TEOS (tetraethoxysilane, a non-functional silica precursor forming the siloxane network) as co-precursors. The GPMDES-modified film exhibited a higher surface roughness (Sa = 4.9 nm) and stronger hydrophilicity (water contact angle = 18°) compared to the GPTES-modified film (Sa = 3.7 nm, contact angle = 36°), despite the presence of a hydrophobic methyl group. The incorporation of glycidyl groups significantly improved interfacial adhesion: the CNC/GPMDES/TEOS film achieved an adhesion strength of 23 mN/mm to chitosan, nearly double that of the CNC/TEOS film (12 mN/mm). The results suggest that both the surface roughness and the reactive functional groups contribute to wettability and bonding performance.
2.4.5. Laser and Electron Beam Patterning
Liu H. et al. [109] reported a method using CO2 photolithography in order to transfer a crossed groove/column. A tetrapeptide consisting of Arginine-Glycine-Aspartic acid-Serine (H-Arg-Gly-Asp-Ser-OH, RGDS) was immobilized as a fibronectin onto the column platform surface and a micropatterned BC (RGDS-MPBC) occurred (Figure 10). The resulting spongy BC was not destroyed after hydration and was used for cell culture assays studies in which it demonstrated enhanced cytotoxicity to mouse fibroblasts L929, compared to the untreated BC. Moreover, the MPBC had a higher water contact angle of 172° again compared to untreated BC.
Figure 10.
Fabrication and application of RGDS-functionalized micropatterned bacterial cellulose (RGDS-MPBC) films. The process begins with freeze-dried bacterial cellulose (BC), which is then immersed in an RGDS peptide solution to promote cell adhesion. The RGDS-modified BC is subsequently micropatterned using laser-based techniques to generate specific topographies -Column, Woven, and Maze- as shown in the 3D surface images. After a final freeze-drying step, the RGDS-MPBC film is ready for biomedical application. The illustration highlights its use as a wound healing patch in a mouse model, where the micropatterned and biofunctional surface supports improved skin regeneration. Reproduced with permission from reference [109].
In another work, two laser sources operating in different wavelengths—IR (CO2, 10,600 nm) and UV (tripled Nd: YVO4, 355 nm) were applied to create the Pitcher-plant topography on BC for cell-contact guidance applications. The authors reported the fabrication of different topographies with parallel grooves featuring a 20–300 μm periodic structures on the BNC [110].
In another highly interesting approach, Wang Jing et al. [111] introduced a laser-patterned bacterial cellulose (BC) hydrogel scaffold designed for bone tissue engineering. Using a CO2 excimer laser, they created regular vertical pore arrays (200–300 μm) in the BC membrane (MP-BC) to overcome its inherent low porosity. The patterned BC was further coated with gelatin (MP-BC/Gel) using procyanidin as a natural cross-linker, and then hydroxyapatite (HAp) crystals were deposited on the surface via a biomimetic mineralization process. SEM imaging confirmed that the gelatin and HAp formed thin, continuous layers on the nanofibrous BC without disrupting its original 3D structure.
Building on previous strategies that used laser patterning of bacterial cellulose for tissue engineering, Hu et al. [112] explored a surface-engineered BC hydrogel designed to promote scar-free skin healing. In this study, a crossed groove/column micropattern (columns: ~100 × 100 μm; grooves: ~150 μm wide) was fabricated on spongy BC membranes using low-energy CO2 laser photolithography (10 W). In vivo studies on rat dorsal wounds showed that RGDS-MPBC significantly improved wound closure and minimized scar formation compared to pristine BC and gauze controls. This design mimicked the “basket-woven” collagen architecture of healthy skin, contrasting with the dense, aligned fibers of scar tissue, and demonstrated strong potential for advanced wound healing therapies.
Ganner et al. [113] demonstrated a method for functionalizing nanoscale cellulose based on focused electron beam induced conversion (FEBIC). In this method, trimethylsilyl cellulose (TMSC) was first applied onto Si/SiO2 substrates by spin-coating and then selectively irradiated with a focused electron beam. The exposure induced a localized chemical reaction that removed the silyl groups, converting the soluble TMSC into insoluble cellulose. After washing away the unexposed areas, well-defined cellulose nanostructures remained, featuring lateral dimensions as small as ~70 nm—all accomplished without the need for masks, high temperatures, or chemical developers. The cellulose that formed kept its chemical properties and could still be broken down by enzymes, confirming that its structure was unchanged. Overall, this technique provides a flexible way to create cellulose nanostructures for use in areas like bioelectronics, microfluidics, and surface engineering.
2.4.6. Ex Situ Imprinting Methods
Roig-Sanchez et al. [76], except the in situ biolithography method presented earlier, structured bacterial cellulose films with pillars patterns by soft imprinting of BC films using PDMS stamp on wet films, the structured films are then dried either using OD or SCD. The OD method used a 1 kg weight to apply pressure during drying, while SCD involved solvent exchange before drying at high pressure. Using this soft-imprint lithography, patterning is performed during the film drying. The PDMS stamp was patterned with square columns of 200 μm base size and 140 μm depth. It was found that x and y dimensions are maintained, whereas the z is considerably reduced (~99%), Additionally, PDMS mold resolution influenced the replication of fine structures, with features below 20 µm tending to lose their original shape. The study concluded that soft-imprint lithography, despite its limitations in structural integrity, enables submicron feature fabrication with potential applications in optical devices (Figure 11). Further optimization of process parameters could enhance the applicability of both techniques in fields such as flexible electronics, biosensing, and transient sensors.
Figure 11.
Schematic of the soft-imprint lithography method. Using this method, after harvesting and cleaning of the BC film it is left to dry in contact with a patterned PDMS mold for 12 h at 60 °C by applying pressure using a 1 kg weight. (A–C) The surface pattern characterization is also shown. The replication accurancy is presented in (A), surface profile is shown in (B) and actual images of the films are illustrated in (C). The reproducibility is excellent in x and y dimensions, and it is significantly lower in z dimension. Reproduced with permission from reference [76].
Within the framework of ex situ imprinting techniques, Espinha et al. [114] used soft nanoimprinting methods to form periodic nanostructures with optical (photonic/plasmonic) properties from hydroxypropyl cellulose (HPC). They applied two approaches (a) hot embossing and (b) soft stamp patterning using patterned PDMS stamps to transfer nanostructures onto HPC films. This allowed them to create regular surface patterns (square, hexagonal, and grating) with feature sizes smaller than 1 μm, starting from simple water-based HPC solutions, without needing complex molecular self-assembly. The films showed structural colors that changed depending on the viewing angle, and the reflected colors could be tuned by adjusting the spacing of the patterns. Unlike other systems where color comes from internal ordering (like chiral nematic phases), here, the effect came purely from the surface patterns. In their original form, the membranes were biodegradable and water-soluble, meaning they could dissolve in water. To make them water-stable, they used two options: either crosslinking the HPC with divinyl sulfone, or replacing it with acetyl cellulose, which does not dissolve. Finally, by adding a thin silver layer, they turned the films into plasmonic materials that could enhance light signals and, for example, they improved photoluminescence (by 10×) and enabled SERS detection of small molecules like thiophenol. This work shows how soft lithography can be used to make eco-friendly, functional cellulose materials for optical and sensing applications.
Continuing within the framework of ex situ imprinting techniques, Zhou et al. [115] presented a solvent-assisted soft nanoimprint lithography method to create patterned cellulose films using cellulose nanocrystals (CNCs). The process involved spin-coating aqueous CNC dispersions containing citric acid as a crosslinker and sodium hypophosphite as a catalyst onto a substrate. Patterned PDMS stamps were then used to imprint the films, followed by mild thermal treatment. This resulted in crosslinked CNC films with well-defined nanostructures such as gratings, nanopillars, and nanoholes, with lateral features reaching down to 140 nanometers.
To improve pattern quality at smaller scales modified the interaction between the CNC dispersion and the stamp by either adding a siloxane-based surfactant or coating the PDMS with polydopamine (PDA). These changes improved wettability, reduced contact angles, and enabled more accurate transfer of fine features. The study also introduced a reverse imprinting method, where the CNC solution was first applied to the stamp and then transferred to the substrate. This approach worked better for patterns with larger heights and more complex topography, such as Sharklet-inspired structures. After crosslinking, the patterned cellulose films became water-stable, unlike the original CNC films which were water-soluble. This method offers a practical and scalable way to produce functional, structured cellulose surfaces for applications in optics, biointerfaces, and surface engineering.
3. Current and Emerging Applications of Functionalized BC Membranes
Bacterial cellulose is a flexible material that can be modified using a plethora of wet and dry methods, either during the production step or even after it is produced. These methods enable the use of BC in a wide range of applications as shown in Figure 12i [116]. More specifically, in biomedicine, BC is particularly valuable for applications like wound care, artificial skin, vascular grafts, dental implants, and bone/cartilage regeneration, as well as for scaffolding in nerve repair [117,118]. In ophthalmology, BC is applied in corneal regeneration, while its strength and flexibility make it suitable for vascular grafts. It is also used in contact lenses, tympanic membranes, and artificial corneas [119]. Its porous structure also enables controlled drug delivery through the skin, and when combined with antimicrobial nanoparticles like silver or zinc oxide, BC helps treat infections by killing bacteria. Current research focuses on improving BC’s biomedical applications by optimizing production using affordable food sources and enhancing its properties through composite materials [120].
BC has recently also attracted great interest in food packaging due to its unique physicochemical properties. It is nontoxic, exhibits high mechanical strength and can be easily produced. Most of the studies on oral toxicity of BC report that the consumption of BC has no embryotoxicity, reproductive toxicity or inflammatory reaction [121]. Of course, these studies have been performed on mice. In addition, BC is recognized as safe by the USA Food and Drug Administration [122]. Food packaging made from bacterial cellulose (BC) offers the added benefits of being both edible and biodegradable. Moreover, combined with other polymers, BC can produce more effective biodegradable composites. Despite these advantages, pure BC still lacks critical characteristics required for use in food packaging, particularly its inability to provide antimicrobial and antioxidant properties. As a result, current researchers have focused on developing methods to modify BC, adding the necessary properties to make it a viable material for food packaging and other applications (Figure 12ii) [123].
Figure 12.
(i) Overview of the wide range of applications for functionalized bacterial cellulose (BC). BC serves as a versatile biomaterial across multiple fields, including biomedical applications (wound dressings, tissue scaffolds, cell carriers, antibacterial films), food industry (coatings, additives, fat replacers), environmental and industrial uses (biosensors, superabsorbents, wearable devices, filtration membranes, bioremediation), as well as textiles, packaging, and concrete reinforcement. Reproduced with permission from reference [116] (ii) Schematic representation of BC synthesis from bacterial cultures and its subsequent modification with natural and synthetic additives (e.g., chitosan, polylysine, anthocyanins) to form biocomposites with enhanced properties. These modifications improve BC’s mechanical strength, antimicrobial activity, shelf life, and biodegradability, making it suitable for advanced food packaging applications. Reproduced with permission from reference [123], respectively.
In the following sections, we will present examples of BC materials applied a. for wetting control in order to be used in separation applications and b. as antibacterial surfaces for food- and health-related applications.
3.1. Wetting Control of Functionalized Bacterial Cellulose and Cellulose for Separation Applications
Superhydrophobic/superoleophilic reinforced ethylcellulose (SEC) sponges for oil/water separation applications which have been fabricated by cross-linking ethylcellulose (EC) with epichlorohydrin (ECH) and integrate silanized carbon nanotubes (Si-CNTs) and coatings with SiO2 nanoparticles modified with hexadecyltrimethoxysilane (HDTMS) have been reported. This combination of materials endowed the sponges with superhydrophobicity (water contact angle = 158.2°) and superoleophilicity (oil contact angle = 0°), along with excellent mechanical durability, sustaining pressures up to 28.6 kPa without damage (Figure 13i). The sponges exhibited density lower than 20 mg/cm3, 98% porosity, and exceptional oil absorption up to 64 times higher than their own weight. They also demonstrated stability in harsh environments, including acidic, alkaline, and saline conditions. After 50 separation cycles, the absorption capacity retained 86.4% of its initial value, highlighting its recyclability and durability [124].

Figure 13.
(i) Water droplet images and contact angle measurements of (a) C2, (b) R3, and (c) SEC sponges using water, HCl (1 M), NaOH (1 M), and NaCl (10 wt%) droplets, demonstrating their superhydrophobic and chemically resistant surfaces. Reproduced with permission from reference [124]. (ii) (a) UV–vis absorbance spectra of methylene blue (MB) dye feed solutions and filtrates after filtration through all-cellulose composite membranes at different flow rates (b) Corresponding removal efficiencies. (c) Visual comparison of filtrates and feed solutions at varying MB concentrations (5–100 ppm) (d) MB removal efficiency as a function of dye concentration. Reproduced with permission from reference [125]. (iii) Adsorption capacities of native (NFBC) and chemically modified (EDNFBC) nanofibrillated bacterial cellulose for different heavy metal ions (Hg2+, Pb2+, Cu2+, Cd2+, Cr6+, Mg2+), showing enhanced performance after modification. Reproduced with permission from reference [126].
In a study by Chenghong Ao et al. [125], it was reported that the fabrication of an eco-friendly and biodegradable all-cellulose composite membrane by a simple and green dip-coating technique. The membrane was superhydrophilic, underwater superoleophobic, and had ultralow oil adhesion, making it highly effective for wastewater treatment. The membrane exhibited excellent separation efficiency (98.1%) of surfactant-stabilized oil-in-water emulsions and ultrafast dye removal (98.6%), both solely by gravity, rendering the process energy efficient. The water flux was 45 L h−1 m−2, which was superior to most of the existing membranes. The membrane also exhibited good reusability with high separation efficiency upon repeated cycles. Further tests confirmed that the membrane was able to simultaneously separate insoluble oils (e.g., toluene) and soluble dyes (e.g., methylene blue, MB). Both the oil/water separation efficiency and the dye removal efficiency were higher than 95% after eight filtration cycles, demonstrating its durability and recyclability (Figure 13ii).
In another work, the objective was to improve the adsorption properties of nano-fibrillated bacterial cellulose (NFBC) through chemical modification of its surface using EDTA monoanhydride [126]. NFBC possesses a high surface area and aspect ratio and thus can be used as an adsorbent, although it does not contain functional groups for binding metal ions. By grafting EDTA onto NFBC, a material has been prepared that possesses the ability to selectively adsorb heavy metal ions such as Cu(II), Hg(II), Pb(II), and Cd(II) with negligible adsorption of Mg(II) and Cr(VI). The EDTA-grafted NFBC showed excellent stability and recyclability, with no loss of adsorption capacity over five adsorption and desorption cycles. Compared to the other EDTA-functionalized cellulose materials reported previously, which could only be used in fabrics or filters, the new modified NFBC is more flexible, and it can be shaped into different forms, including filters and aerogels. Of particular interest is its high selectivity for heavy metal ions, rendering it an excellent candidate for wastewater treatment and heavy metal remediation, thus providing an environmentally friendly and recyclable approach to environmental pollution control (Figure 13iii).
In the work by Radwa M. Ashour et al. [127], a bacterial cellulose nanocomposite was synthesized using water as solvent by immobilizing MIL-100(Fe) (Fe (III) 1,3,5-benzenetricarboxylate) onto bacterial cellulose (BC) nanofibers. The bacterial cellulose (BC) was used as structural support for the lyophilisation of the MIL-100(Fe). The resulting composite was flexible and light weight. The study showed that the size of the Fe particles could be tuned by controlling the precursors ratio. The resulting nanocomposite was reported to be efficient in removal of As(III) and Rhodamine B from aqueous solutions and exhibited adsorption capacities up to 4.81 mg g−1.
Zheng Cheng et al. [128] reported a highly porous and mechanical resilient bacterial cellulose (BC) carbon aerogel fabricated by freeze drying BC hydrogel and subsequent high-temperature carbonization. The aerogel exhibited good mechanical properties (i.e., compressibility ~99.5%) and elastic recovery). The BC carbon aerogel was applied for oil/water separation and exhibited oil absorption capacity as high as 132–274 g g–1. The authors also reported that the material could be reused after 20 successive absorption/combustion cycles.
Staying within the theme of wetting control and surface functionalization for separation applications, Wang et al. [129] developed superhydrophobic membranes from bacterial cellulose (BC) blended with needle-leaf bleached kraft pulp (NBKP) for gravity-driven oil/water separation. The BC/NBKP composite was modified with copper hydroxide nanoparticles to enhance roughness and then coated with stearic acid (SA), resulting in a petal-like microstructure. The final membrane (BN-CuSA2) showed a water contact angle of 162.3°, confirming its superhydrophobic character, while its oil contact angle dropped to 0°, indicating strong oil affinity. The membrane enabled efficient gravity-based separation, achieving over 95% separation efficiency for a variety of oils. Its oil flux reached up to 1667.6 L·m−2·h−1, and it retained both hydrophobicity and performance after 10 reuse cycles. The surface remained stable after acidic, alkaline, saline treatments, sandpaper abrasion, UV exposure, and ultrasound in ethanol, with water contact angles consistently above 140°. Additionally, it exhibited self-cleaning and anti-fouling capabilities.
Continuing with the development of functionalized cellulose materials for separation applications, He et al. [130] introduced a composite aerogel made from bacterial cellulose (BC) and silica, designed for efficient oil absorption and recovery. The bacterial cellulose structure was soaked in a silica-based solution under vacuum and then freeze-dried, resulting in a light, solid aerogel with a stable porous structure. The final material combined large pores from the BC network with mesopores from the silica component, offering both flexibility and high surface area. The aerogel showed superhydrophobic behavior, with a water contact angle of 152°, and strong affinity for oil. It could absorb a wide range of oils and organic solvents at high capacity, reaching quality factors between 8 and 14. The structure remained stable at temperatures from −200 °C to 300 °C and could recover its shape after being compressed up to 80%. Oil could be removed by simply squeezing the aerogel, with a recovery efficiency of 88%.
Huazheng Sai et al. [131] worked on enhancing bacterial cellulose aerogels (BCAs) for oil/water separation by modifying only the surface of their nanofibrous structure using a liquid-phase trimethylsilylation process. Starting from freeze-dried bacterial cellulose obtained from nata de coco, they treated the material with trimethylchlorosilane (TMCS) in dichloromethane to render it hydrophobic, followed by ethanol washing and re-drying. This method preserved the original 3D web-like network of ultrathin (20–80 nm) fibers and key physical properties like ultralow density (≤6.77 mg/cm3), high porosity (~99.6%), and high surface area (≥169.1 m2/g), while achieving low surface substitution (DS ≤ 0.132). The resulting hydrophobic BCAs (HBCAs) showed water contact angles up to 146.5°, strong oil affinity, and selective oil absorption from water. They could absorb a wide range of oils and solvents with capacities up to 185 g of liquid per gram of aerogel, depending on the liquid’s density. The materials also demonstrated excellent reusability: after 10 cleaning and reabsorption cycles using compression, rinsing, and freeze-drying, they retained nearly full absorption capacity and structural integrity. Yuanyuan Xu et al. [132] developed an amino-functionalized bacterial cellulose/MXene (ABC/MX) composite using an electrostatic self-assembly strategy for wastewater treatment. Their goal was to enhance pollutant removal efficiency by enriching active sites and improving interfacial interactions. They modified bacterial cellulose nanofibers with polydopamine and polyethyleneimine to introduce amino groups, which improved binding with negatively charged Ti3C2Tx MXene nanosheets. This composite exhibited a 3D porous structure. The authors evaluated the adsorption performance of the ABC/MX composite against Cr (VI) and Congo Red (CR) under various pH, concentration, and temperature conditions. The ABC/MX showed high adsorption capacities of 200.7 mg/g for Cr (VI) and 1103.7 mg/g for CR at 320 K, significantly outperforming controls.
In the study of Guo et al. [133], bacterial cellulose hydrogels (BCH) were fabricated and used as a green template for the in situ growth of ZnO nanoflowers, forming BCH/ZnO composites. These were then processed into an aerogel (BCA/ZnO-3) via freeze-drying and a membrane (BCM/ZnO-3) via heat-drying. The materials were thoroughly characterized and tested for multifunctional water purification capabilities, including ultrafiltration and adsorption. Key mechanisms such as electrostatic interaction, hydrogen bonding, and size exclusion enabled simultaneous removal of heavy metals, dyes, antibiotics, and bacteria from contaminated water. In particularly, BCA/ZnO-3 achieved a treatment capacity of 773.8 L·m−2 in an injection-driven filter, while BCM/ZnO-3 reached 674 L·m−2 under 2.5 bar pressure. BCM/ZnO-3 also demonstrated a high flux (29.19 L·m−2·h−1), excellent reusability, and full disinfection of E. coli and S. aureus.
3.2. Antibacterial Action of Functionalized Bacterial Cellulose and Cellulose for Food Packaging and Wound Healing Applications
As pointed out earlier, surfaces with antibacterial properties can find numerous applications in several scientific fields. Of course, BC has also been proposed as an excellent candidate for many biomedical applications [119]. Viruses and bacteria are present in many aspects of our daily lives. The rapid growth and reproduction of these microorganisms in humid conditions can lead to significant economic losses and pose health risks [134]. On top of that, it is well known that food waste causes significant social, economic, and environmental challenges, and reducing bacterial contact with food is key to preserving its quality and extending shelf life [135,136]. To this end, many works have focused on the incorporation of antibacterial or bactericidal properties on BC and cellulose. To do so, both in situ as well as ex situ methods have been used.
For example, BC was treated with copper acetate (CA) and dopamine hydrochloride (DA) to synthesize copper-based nanoparticles and polydopamine, aiming to improve antibacterial activity, mechanical strength, and hydrophobicity. The modification process involved treating BC with varying concentrations of CA and DA in both single and two-step methods. The optimal sample, containing 10 w/w% CA and 0.5 g/L DA, was selected based on its superior antibacterial properties. Characterization techniques, including FTIR-ATR, FESEM, and water contact angle analysis, confirmed the successful deposition of copper nanoparticles and DA onto the BC surface. The modifications led to significant improvements in several properties. Antibacterial tests showed a 99.8% and 99.9% bacterial reduction against Escherichia coli and Staphylococcus aureus, respectively. The tensile strength of the modified BC increased by 206%, while its water contact angle rose from 18° to 89°, reducing hydrophilicity and enabling the material to float on water. Additionally, the DA-treated BC exhibited photothermal properties, with the temperature rising from 44 °C (raw BC) to 60 °C in 3 min under sunlight exposure. Furthermore, biocompatibility assessments demonstrated cell viability of 76–78%, confirming the material’s low toxicity. These modifications resulted in a unique combination of antimicrobial activity, enhanced mechanical properties, controlled hydrophilicity, and photothermal effects [137].
In another work, bacterial cellulose–silver nanoprism composite was produced and found effective for detoxifying endosulfan and disinfecting water contaminated with E. coli. The composite, with silver nanoprisms (7–37 nm) doped onto bacterial cellulose, removes >99% of endosulfan and bacteria while maintaining reusability for multiple cycles with minimal silver leaching. This approach enhances nanoparticle stability, reduces environmental risks, and lowers water treatment costs [138]. Further research is needed to optimize silver deposition for improved recyclability and efficiency.
In a more recent work, Fatima et al. [65] developed ex situ BC membranes enhanced with Sage and Neem extracts in order to study the possible antimicrobial effects, while as culture media fruit waste was used. Indeed, neem and sage extracts, which were obtained via Soxhlet extraction, demonstrated strong antibacterial activity against E. coli and S. aureus as they were incorporated into BC membranes, forming BC-Neem (BC-N) and BC-Sage (BC-S) composites. The FTIR confirmed chemical interactions, while SEM revealed structural integration and plus both BC-N and BC-S exhibited high water-holding capacity, absorbing nearly 90 times their dry weight. Moreover, antibacterial assays showed BC-N significantly inhibited S. aureus (78%) and E. coli (51%), whereas BC-S reduced S. aureus by 48% and agar disk-diffusion tests further confirmed BC-N’s superior antibacterial effect.
In another effort, ZnO/BC composites exhibited strong antibacterial activity, making them suitable for antibacterial applications against E. coli and S. sureaus. The results showed that the BC played a crucial role on the morphology of ZnO nanofibers (Figure 14i) [91].
According to another study by Pal et al. [139], silver-functionalized bacterial cellulose (Ag/BC) was developed as an antibacterial membrane for wound-healing applications. The researchers introduced silver nanoparticles (AgNPs) into the three-dimensional porous network of bacterial cellulose using an eco-friendly photochemical method based on UV light exposure. These nanoparticles were both distributed throughout the cellulose structure and chemically bonded to the surface of the cellulose fibers. The antibacterial effectiveness of the Ag/BC materials was evaluated against Escherichia coli using both inhibition zone measurements and bacterial growth studies. Membranes treated with a silver nitrate solution at a concentration of 10−2 M exhibited the strongest antibacterial effect, with clear zones of bacterial suppression and a marked reduction in bacterial proliferation over 100 h.
According to another study by Shao et al. [140], bacterial cellulose (BC) membranes were chemically modified with aminoalkylsilane groups to create bioactive surfaces with strong antibacterial properties. The functionalization was achieved through grafting (3-aminopropyl) triethoxysilane (APTES) onto BC membranes using a polycondensation method, forming a stable polysiloxane network chemically bonded to the cellulose surface. The antibacterial performance of A-g-BC membranes was evaluated against Escherichia coli, Staphylococcus aureus, Bacillus subtilis, and Candida albicans using a plate count method. Results showed that bacterial and fungal adhesion decreased significantly as the grafting level increased, with the highest modification (BC10) achieving up to 100% reduction in E. coli and over 98% reduction for the other microorganisms (Figure 14ii).
Fernandes et al. [141] reported antimicrobial and biocompatible bacterial cellulose (BC) membranes which were engineered through chemical surface functionalization with aminoalkyl groups. The researchers added 3-aminopropyltrimethoxysilane (APS) onto the BC nanofibrils by immersing the membranes in a silane-acetone solution, followed by thermal curing and Soxhlet extraction. This modification resulted in a stable polysiloxane network chemically bonded to the cellulose surface. The antibacterial activity was evaluated against S. aureus and E. coli using the Dynamic Shake Flask Method. Results demonstrated a significant reduction in bacterial numbers, with over 3-log reductions for both strains, confirming the effectiveness of the surface modification (Figure 14iii).
Figure 14.
(i) Antibacterial activity of ZnO/BC nanocomposite membranes against Escherichia coli (A) and Staphylococcus aureus (B) using the agar diffusion method.Τhe samples include unmodified bacterial cellulose (BC) as control (a), and BC membranes loaded with different concentrations and types of Zn2+ precursors: 0.50Zn(NO3)2/SPP/BC (b), 1.00Zn(NO3)2/SPP/BC (c), 5.00Zn(NO3)2/SPP/BC (d), 10.00Zn(NO3)2/SPP/BC (e), 10.00Zn(CH3COO)2/SPP/BC (f), and 20.00Zn(NO3)2/SPP/BC (g). Increasing Zn2+ content correlates with larger inhibition zones, indicating enhanced antibacterial performance. Reproduced with permission from reference [91]. (ii) Quantification of microbial adhesion on aminated bacterial cellulose (A-g-BC) membranes against four different microorganisms: (A) E. coli, (B) S. aureus, (C) B. subtilis, and (D) C. albicans. A significant decrease in the number of colony-forming units (CFU/cm2) is observed with increasing degree of surface functionalization, demonstrating improved anti-adhesive and antimicrobial properties. Reproduced with permission from reference [140]. (iii) Evaluation of the antimicrobial effect of aminated BC (BC-NH2) membranes after 24 h against S. aureus and E. coli. Results are compared with unmodified BC membranes and positive control (inoculated broth with 5% nutrient broth). BC-NH2 shows a substantial reduction in bacterial count, confirming its bactericidal activity. Reproduced with permission from reference [141].
In another study, an antimicrobial material was prepared by adding silver nanoparticles (Ag NPs) on bacterial cellulose (BC). For this purpose, BC films were first treated with low-pressure oxygen–nitrogen plasma, which created new oxygen-containing functional groups on the surface of the polymer. This enabled stable fixation of Ag NPs, which were deposited on the BC surface by magnetron sputtering [89]. Antimicrobial activity of plasma-treated BC (BCP-Ag) against Aspergillus niger, Staphylococcus aureus, and Bacillus subtilis was evaluated and was observed to have excellent resistance against bacterial and fungal growth. XPS analysis also confirmed that the plasma treatment had modified the BC surface through the oxidation of alcohol groups and the opening of oxypyran rings, which was possibly accountable for Ag NP stabilization. The findings indicate that the synergism of plasma treatment and Ag NP deposition yields a long-lasting and environmentally friendly antimicrobial material. The findings point to the potential application of BCP-Ag films in medicine, especially for the inhibition of bacterial and fungal infections in wound dressings and other biomedical devices.
Qiu et al. [142] used a layer-by-layer self-assembly technique with modified TiO2 and ε-polylysine to enhance cellulose papers, achieving high antibacterial activity against E. coli and S. aureus Additionally, wound dressings can be made from both natural and synthetic polymers. Natural polymers are especially favored because of their excellent biocompatibility, biomimetic properties, and physicochemical properties. The efficiently controlled release of active ingredients should be guaranteed by biopolymer-based wound dressings, whose rate of degradation must be synchronized with the wound healing process.
Wound healing is a complex physiological process affected by various factors, which can lead to delayed healing, infection, and inflammation [143]. Therefore, selecting the right wound dressing is essential to effectively manage and guide the healing process. BC, as a promising new material for wound dressings, has garnered increasing attention. Bacteria can produce cellulose through a biosynthetic pathway that involves secreting polysaccharides from carbon sources [144]. BC has excellent mechanical and physical properties, biocompatibility, and biodegradability [145]. Unlike plant-derived cellulose, BC is purer, easier to purify, and has a three-dimensional (3D) network structure like the extracellular matrix, making it a strong candidate for applications in tissue engineering, wound healing, and vascular regeneration [146,147,148]. Moreover, BC has potential in various fields such as drug delivery, bioprinting, implants, and artificial organs [149,150,151]. Despite its numerous benefits for wound healing, BC lacks inherent antibacterial properties, which limits its use in wound dressings [152]. The antibacterial action of dressing is essential for preventing infection and for enhancing healing.
To address this limitation, many studies have focused on developing BC-based composite materials with added antibacterial properties. While BC itself does not have inherent antibacterial activity, it can be modified to enhance its antimicrobial properties. BC’s high porosity and surface area make it ideal for incorporating and slowly releasing antimicrobial agents and other functional materials [153].
According to another research of Khalid et al. [154], a novel antibacterial and regenerative wound dressing was developed by integrating multiwalled carbon nanotubes (MWCNT) into bacterial cellulose (BC) through an ex situ immersion process. This hybrid material aimed to enhance the antibacterial properties of BC and promote tissue regeneration, particularly in diabetic wound healing applications. The composite’s antibacterial efficacy was assessed using a disk diffusion assay against multiple pathogenic strains, including E. coli, S. aureus, MRSA, and P. aeruginosa, where the BC-MWCNT films showed larger zones of inhibition than standard antibiotics. For in vivo evaluation, diabetic mice models were used to test wound healing. The wounds treated with BC-MWCNT showed 99% closure by day 21, significantly outperforming untreated controls (77%). Histological analysis revealed complete re-epithelialization and healthier tissue regeneration in the composite-treated group.
As referred before, in the study by Deng et al. [81], the antibacterial activity of a novel hydrogel was achieved by chemically modifying bacterial cellulose (BC) with aldehyde groups and crosslinking it with quaternized chitosan (QCS). The incorporation of QCS introduced positively charged functional groups (–NH2 and –NR3+) that interact electrostatically with negatively charged bacterial membranes, leading to membrane disruption and bacterial death. This covalently bonded structure (DBC/QCS) allowed the hydrogel to maintain its functionality even after drying and rehydration. The antibacterial performance was tested against Escherichia coli and Staphylococcus aureus using bacterial colony counting and SEM imaging. The DBC/QCS hydrogel showed strong antibacterial effects, achieving killing rates of 80.8% for E. coli and 81.3% for S. aureus.
Finally, in another example, a novel bacterial cellulose (BC) hydrogel with enhanced antibacterial and wound-healing properties was reported [155]. Traditional BC dressings are widely used due to their three-dimensional network structure, but optimizing their antibacterial activity remains a challenge. To address this, researchers incorporated silver-loaded zeolitic imidazolate framework-8 (ZIF-8) into a BC-based hydrogel, creating a functional biopolymer dressing. The stable release of silver (Ag+) and zinc (Zn2+) ions contributed to its antibacterial effectiveness, with bacterial survival rates dropping to just 0.85% for E. coli and 0.39% for S. aureus. Additionally, in vitro cell experiments confirmed the hydrogel’s excellent biocompatibility and angiogenic potential, making it a promising candidate for wound treatment. Further investigations, including in vivo studies in rats, demonstrated the hydrogel’s significant wound-healing abilities and enhanced skin regeneration and epithelialization. The hydrogel observed was effectively facilitated epidermal growth and collagen formation within two weeks, as confirmed by tissue staining.
4. Challenges and Future Perspectives
Cellulose and especially bacterial cellulose (BC) have received growing scientific interest over the last two decades because of its renewability, adjustable structure, and outstanding biocompatibility. However, the native form of cellulose often lacks certain chemical, mechanical, or biological properties necessary for advanced applications. This limitation has prompted a significant increase in research focused on developing functionalization strategies to modify surface chemistry and improve the properties of biomaterials.
Starting from the in situ functionalization methods, such methods usually involve the incorporation of functional additives such as carboxymethylcellulose (CMC), chitosan, or metallic nanoparticles directly during the production of bacterial cellulose. As these compounds are integrated throughout the cellulose matrix during biosynthesis, the resulting material often exhibits improved mechanical properties, enhanced hydrophilicity or porosity and functionalities deriving from the additives (i.e., antibacterial action). In situ methods eliminate the need for post-synthesis modification steps, yet surface structure and chemistry modifications cannot be fulfilled easily, or the options are limited. On top of that, such methods are usually wet, producing significant amounts of waste.
On the other hand, ex situ approaches such as dip coating, electrospinning, or surface chemistry modification offer increased flexibility for combining functional agents and enable precise control over fiber morphology. However, these methods might result in weaker bonding at the interface and have the risk of gradual loss of the functional ingredients. Finally, since most of them are again wet the drawback of the waste produced during functionalization remains unsolved.
To this end, dry ex situ strategies have been proposed. Methods such as plasma processing, embossing, laser patterning which have been extensively used in synthetic polymers have started to gain the attention of the people working in biopolymers for postproduction functionalization. For example, plasma-based techniques, such as cold and low-pressure plasma treatments, have become effective, solvent-free techniques for applying reactive groups or nanoparticles onto the cellulose surface. These methods often improve hydrophobicity, antimicrobial activity, and cell affinity, while preserving the underlying structure. Despite their environmental advantages—such as minimizing the use of hazardous solvents and their demonstrated capacity to functionalize surface properties, plasma treatments require precise control of process parameters (including power, pressure, gas composition, and exposure duration). Additionally, their effectiveness can vary depending on substrate-specific characteristics such as surface roughness, chemical composition, and the presence of residual contaminants. Efforts to develop micro- and nano- patterns through techniques like soft lithography or photolithography have led to bioengineered BC films with specific topographies that direct cell growth, wetting control, or enhance sensing capabilities. These methods, although technically advanced, require careful management of drying conditions and material behavior at micro scales.
On top of that, life cycle assessment (LCA) has emerged as a key methodology to evaluate the full environmental footprint of these materials, from raw material sourcing to end-of-life disposal. BC is increasingly recognized as a sustainable and high-performance alternative to plant-derived cellulose, due to its microbial production from renewable carbon sources, high crystallinity, and minimal post-extraction purification. Aragão et al. [156] conducted a comparative LCA of BC production using the traditional Hestrin-Schramm (HS) medium and an alternative agro-industrial medium based on corn steep liquor (CSL). Their study reported a remarkable reduction—exceeding 98%—in key environmental impact categories, including global warming potential, freshwater pollution, ecotoxicity, and human toxicity. This outcome was largely attributed to the substitution of energy-intensive and synthetic nitrogen sources with CSL, as well as reduced thermal energy requirements during fermentation and drying.
The sustainability of CSL-based fermentation has been supported by additional studies, which emphasize the environmental benefits of using agro-waste such as fruit pulp, molasses, whey, and textile effluent as culture media. Further work by Li et al. [157] demonstrated that jujube-processing wastewater serves as an effective low-cost medium, producing BC with mechanical strength and crystallinity comparable to HS-derived material. Notably, in other work [158] BC produced from these low-cost feedstocks retains comparable mechanical strength, water retention, nanofiber morphology, and crystallinity produced via standard methods, supporting its commercial viability.
From a toxicological and safety point, BC is considered biocompatible, non-toxic, and non-immunogenic, making it suitable for food contact, wound dressings, and tissue engineering. Preclinical studies in rodents have shown that BC has shown no evidence of reproductive toxicity, inflammatory responses, or organ-specific toxicity, even under sub-acute and oral administration. BC functionalized with silver nanoparticles for wound dressings remained biocompatible and non-toxic in preclinical models [159]. However, the functionalization of cellulose membranes, particularly for targeted properties such as antimicrobial activity, hydrophobicity, or conductivity—introduces new sustainability challenges. While green modification techniques (e.g., enzymatic grafting, in situ doping, or plasma treatment) offer promising low-impact routes, alternative strategies using chemical agents, fluorinated derivatives, or metal nanoparticles raise concerns regarding ecotoxicity, bioaccumulation, and long-term environmental persistence. The uncontrolled discharge of metal-based additives (e.g., Ag, ZnO, TiO2) during use or disposal can threaten aquatic ecosystems, particularly if used in single-use products or uncontrolled environments [160]. However, there are examples of green modification methods and materials, such as waxes and natural extracted organic acids, which can be deposited easily and are non-toxic to the environment [161]. Similarly, Tahir et al. [162] emphasized the use of green solvents and bio-based coupling agents in nanocellulose composites to minimize toxicity and encourage biodegradability. Recent publications have further emphasized the importance of integrating end-of-life considerations into material design, calling for biodegradable, safe-by-design nanocomposites to reduce emerging contaminant loads. Such studies argue for the inclusion of nanotoxicity testing and environmental leaching simulations in early-stage functionalization development. For instance, Brennan et al. [163] describe the Safe-by-Design (SbD) framework as an anticipatory strategy that embeds risk assessment into the innovation process of nanomaterials, emphasizing that toxicity, release potential, and exposure scenarios should be evaluated at the R&D stage, not after commercialization. Similarly, Furxhi et al. [164] expanded this concept through the Safe-and-Sustainable-by-Design (SSbD) paradigm, which combines safety with environmental sustainability. They argue that life cycle assessment (LCA), environmental leaching behavior, and degradability should be considered not as afterthoughts, but as core design criteria for functional materials and nanocomposites. These approaches are increasingly recognized as essential tools to guide responsible material innovation while meeting both regulatory and sustainability targets.
To advance the field responsibly, future research must integrate eco-design principles in the development of functionalized BC membranes, emphasizing biodegradability, recyclability, and safer-by-design chemical modification. Moreover, updated LCAs that incorporate the post-functionalization stages are crucial to holistically evaluate the environmental burden of final products.
In Table 2, we summarize some of the most recent (published in the last 5–7 years) and interesting examples for BC functionalization which exist in the literature. We also provide our point of view in terms of industrial scalability, cost and environmental footprint for each method, in an effort to highlight the most promising ones.
Table 2.
Most recently, in situ and ex situ methods for BC functionalization together with the targeted application and the functionality which was improved or added in each case.
It is therefore evident that the applicability of each method relies on the application envisioned. Nevertheless, nowadays the existing tools for the functionalization of bacterial cellulose (BC), have opened revolutionary avenues for designing materials with optimized wetting properties and impressive antibacterial activity. Techniques such as plasma treatment, nanoparticle deposition, and in situ chemical modification enable precise control over surface hydrophilicity and hydrophobicity. By adjusting surface energy and introducing specific functional groups, researchers have developed membranes with switchable wetting characteristics, expanding their versatility across various applications. For example, surfaces with controlled wettability can be used for separation applications, whereas the addition of bactericidal agents enable the realization of surfaces and materials with improved hygiene standards suitable for food packaging or other health applications.
However, in order for all these new functional biobased polymers to reach the commercial stage, there is a clear need for all the functionalization methods to reach a high technology readiness level (TRL). In addition, future research must integrate eco-design principles in the development of functionalized BC membranes, emphasizing biodegradability, recyclability, and safer-by-design chemical modification. Moreover, updated LCAs that incorporate the post-functionalization stages are crucial to holistically evaluate the environmental burden of final products. To fulfill this, the most promising functionalization methods should be tested and then adopted by the industry, which can only be achieved through close collaboration with the scientific community. In summary, functionalized cellulose, especially BC, represents a transformative platform for developing sustainable, multifunctional materials. Collaboration between different key players and people working in multidisciplinary disciplines is the key to unlocking its full potential, if such efforts are carried out, cellulose-based materials are poised to play a central role in the emerging bioeconomy. Yet, their success in real-world applications will depend not only on their functionality, but also on transparent evaluation of their life cycle impacts, safe material design, and responsible scale-up strategies. If all these are followed, then functionalized BC membranes will be able to stand at the intersection of performance and sustainability, offering a versatile and biodegradable platform for next-generation green materials.
Author Contributions
I.N.: methodology, visualization, writing—original draft preparation, writing—review and editing., D.F.: methodology, original draft writing K.E.: Conceptualization, writing—original draft preparation, writing—review and editing, supervision, project administration, funding acquisition. All authors have read and agreed to the published version of the manuscript.
Funding
This research was funded by the project entitled “Next generation green functional surfaces “[EXRCISE]” funded by the Hellenic Foundation for Research and Innovation (H.F.R.I) under the “Basic Research Financing (Horizontal support for all Sciences), National Recovery and Resilience Plan Greece 2.0)”. Grant number [16743].
Conflicts of Interest
The authors declare no conflict of interest.
References
- Hsissou, R.; Seghiri, R.; Benzekri, Z.; Hilali, M.; Rafik, M.; Elharfi, A. Polymer composite materials: A comprehensive review. Compos. Struct. 2021, 262, 113640. [Google Scholar] [CrossRef]
- Dragatogiannis, D.A.; Koumoulos, E.; Ellinas, K.; Tserepi, A.; Gogolides, E.; Charitidis, C.A. Nanoscale Mechanical and Tribological Properties of Plasma Nanotextured COP Surfaces with Hydrophobic Coatings. Plasma Process. Polym. 2015, 12, 1271–1283. [Google Scholar] [CrossRef]
- Ellinas, K.; Gogolides, E. Ultra-low friction, superhydrophobic, plasma micro-nanotextured fluorinated ethylene propylene (FEP) surfaces. Micro Nano Eng. 2022, 14, 100104. [Google Scholar] [CrossRef]
- Ioannou, D.; Shah, P.; Ellinas, K.; Kappl, M.; Sapalidis, A.; Butt, H.J.; Gogolides, E. Antifouling Plasma-Treated Membranes with Stable Superhydrophobic Properties for Membrane Distillation. ACS Appl. Polym. Mater. 2023, 5, 9785–9795. [Google Scholar] [CrossRef]
- Tajeddin, B.; Arabkhedri, M. Polymers and food packaging. In Polymer Science and Innovative Applications: Materials, Techniques, and Future Developments; Elesvier: Amsterdam, The Netherlands, 2020; pp. 525–543. [Google Scholar] [CrossRef]
- Wojnowska-Baryła, I.; Bernat, K.; Zaborowska, M. Plastic Waste Degradation in Landfill Conditions: The Problem with Microplastics, and Their Direct and Indirect Environmental Effects. Int. J. Environ. Res. Public Health 2022, 19, 13223. [Google Scholar] [CrossRef] [PubMed]
- Zhou, C.; Fang, W.; Xu, W.; Cao, A.; Wang, R. Characteristics and the recovery potential of plastic wastes obtained from landfill mining. J. Clean. Prod. 2014, 80, 80–86. [Google Scholar] [CrossRef]
- Samir, A.; Ashour, F.H.; Hakim, A.A.A.; Bassyouni, M. Recent advances in biodegradable polymers for sustainable applications. Npj. Mater. Degrad. 2022, 6, 68. [Google Scholar] [CrossRef]
- Urbina, L.; Corcuera, M.Á.; Gabilondo, N.; Eceiza, A.; Retegi, A. A review of bacterial cellulose: Sustainable production from agricultural waste and applications in various fields. Cellulose 2021, 28, 8229–8253. [Google Scholar] [CrossRef]
- Rao, M.G.; Bharathi, P.; Akila, R.M. A Comprehensive Review on Biopolymers. Sci. Revs. Chem. Commun. 2014, 4, 61–68. [Google Scholar]
- Hernández, N.; Williams, R.C.; Cochran, E.W. The battle for the “green” polymer. Different approaches for biopolymer synthesis: Bioadvantaged vs. Bioreplacement. Org. Biomol. Chem. 2014, 12, 2834–2849. [Google Scholar] [CrossRef]
- Suarato, G.; Bertorelli, R.; Athanassiou, A. Borrowing From Nature: Biopolymers and Biocomposites as Smart Wound Care Materials. Front. Bioeng. Biotechnol. 2018, 6, 137. [Google Scholar] [CrossRef]
- Yadav, C.; Saini, A.; Zhang, W.; You, X.; Chauhan, I.; Mohanty, P.; Li, X. Plant-based nanocellulose: A review of routine and recent preparation methods with current progress in its applications as rheology modifier and 3D bioprinting. Int. J. Biol. Macromol. 2021, 166, 1586–1616. [Google Scholar] [CrossRef]
- Boateng, J.; Catanzano, O. Advanced therapeutic dressings for effective wound healing—A review. J. Pharm. Sci. 2015, 104, 3653–3680. [Google Scholar] [CrossRef] [PubMed]
- Cui, C.; Gao, L.; Dai, L.; Ji, N.; Qin, Y.; Shi, R.; Qiao, Y.; Xiong, L.; Sun, Q. Hydrophobic Biopolymer-Based Films: Strategies, Properties, and Food Applications. Food Eng. Rev. 2023, 15, 360–379. [Google Scholar] [CrossRef]
- Barthlott, W.; Neinhuis, C. Purity of the sacred lotus, or escape from contamination in biological surfaces. Planta 1997, 202, 1–8. [Google Scholar] [CrossRef]
- Ivanova, E.P.; Hasan, J.; Webb, H.K.; Truong, V.K. Natural bactericidal surfaces: Mechanical rupture of Pseudomonas aeruginosa cells by cicada wings. Small 2012, 8, 2489–2494. [Google Scholar] [CrossRef]
- Pogodin, S.; Hasan, J.; Baulin, V.A.; Webb, H.K.; Truong, V.K.; Phong Nguyen, T.H.; Boshkovikj, V.; Fluke, C.J.; Watson, G.S.; Watson, J.A.; et al. Biophysical model of bacterial cell interactions with nanopatterned cicada wing surfaces. Biophys. J. 2013, 104, 835–840. [Google Scholar] [CrossRef]
- Jana, S.; Mondal, S.; Bhattacharyya, S.R. Wetting and surface energy of vertically aligned silicon nanowires. J. Nanosci. Nanotechnol. 2013, 13, 3983–3989. [Google Scholar] [CrossRef]
- Eral, H.B.; ’t Mannetje, D.J.C.M.; Oh, J.M. Contact angle hysteresis: A review of fundamentals and applications. Colloid Polym. Sci. 2013, 291, 247–260. [Google Scholar] [CrossRef]
- Wu, Y.; Qian, Z.; Lei, Y.; Li, W.; Wu, X.; Luo, X.; Li, Y.; Li, B.; Liu, S. Superhydrophobic modification of cellulose film through light curing polyfluoro resin in situ. Cellulose 2018, 25, 1617–1623. [Google Scholar] [CrossRef]
- Park, S.B.; Lih, E.; Park, K.S.; Joung, Y.K.; Han, D.K. Biopolymer-based functional composites for medical applications. Prog. Polym. Sci. 2017, 68, 77–105. [Google Scholar] [CrossRef]
- George, A.; Sanjay, M.R.; Srisuk, R.; Parameswaranpillai, J.; Siengchin, S. A comprehensive review on chemical properties and applications of biopolymers and their composites. Int. J. Biol. Macromol. 2020, 154, 329–338. [Google Scholar] [CrossRef]
- Sun, X.; Sun, H.; Zhu, P.; Wu, Y.; Palmer, A.; Jiang, F. Transforming Cellulose Into Functional Three-Dimensional Structures. Adv. Funct. Mater. 2025, 2504778. [Google Scholar] [CrossRef]
- Vessally, E.; Rovnag, R. Recent advances in polysaccharide-based nanocomposites as wound healing and transdermal drug delivery systems: A review. Int. J. Biol. Macromol. 2025, 144743, in press. [Google Scholar] [CrossRef]
- Sahil Panjabrao, A.; Hamid; Dash, K.K.; Kathuria, D.; Shams, R.; Chavan, P.; Mukarram, S.A.; Kovács, B. Sustainable 3D-Printed food packaging from agricultural waste: A review of materials, properties, and applications. J. Agric. Food Res. 2025, 22, 102061. [Google Scholar] [CrossRef]
- Shigrekar, M.; Amdoskar, V. A review on recent progress and techniques used for fabricating superhydrophobic coatings derived from biobased materials. RSC Adv. 2024, 14, 32668–32699. [Google Scholar] [CrossRef]
- Azeredo, H.M.C.; Barud, H.; Farinas, C.S.; Vasconcellos, V.M.; Claro, A.M. Bacterial Cellulose as a Raw Material for Food and Food Packaging Applications. Front. Sustain. Food Syst. 2019, 3, 7. [Google Scholar] [CrossRef]
- Zhou, H.; Li, Q.; Zhang, Z.; Wang, X.; Niu, H. Recent Advances in Superhydrophobic and Antibacterial Cellulose-Based Fibers and Fabrics: Bio-inspiration, Strategies, and Applications. Adv. Fiber Mater. 2023, 5, 1555–1591. [Google Scholar] [CrossRef] [PubMed]
- Brogniart, A.; Pelonze, A.B.; Dumas, R. Rapport sur un mémoire de M. Payen, relative à la composition de la matière ligneuse. Comptes Rendus 1839, 8, 51–53. Available online: https://www.biodiversitylibrary.org/item/20576#page/8/mode/1up (accessed on 6 June 2025).
- Lehrhofer, A.F.; Goto, T.; Kawada, T.; Rosenau, T.; Hettegger, H. The in vitro synthesis of cellulose—A mini-review. Carbohydr. Polym. 2022, 285, 119222. [Google Scholar] [CrossRef]
- Berman, J.; Chadwick, S.S. Ullmann’s Encyclopedia of Industrial Chemistry. Ref. Serv. Rev. 1988, 16, 31–34. [Google Scholar] [CrossRef]
- Staudinger, H. Über Polymerisation. Eur. J. Inorg. Chem. 1920, 53, 1073–1085. [Google Scholar] [CrossRef]
- Kobayashi, S.; Shoda, S.I.; Kashiwa, K. Enzymatic polymerization. The first In Vitro synthesis of cellulose via non-biosynthetic path catalysed by cellulase. Am. Chem. Soc. Polym. Prepr. Div. Polym. Chem. 1991, 32, 417–418. [Google Scholar] [CrossRef]
- Kontturi, E.; Tammelin, T.; Österberg, M. Cellulose—Model films and the fundamental approach. Chem. Soc. Rev. 2006, 35, 1287–1304. [Google Scholar] [CrossRef] [PubMed]
- Das, A.; Ringu, T.; Ghosh, S.; Pramanik, N. A comprehensive review on recent advances in preparation, physicochemical characterization, and bioengineering applications of biopolymers. Polym. Bull. 2023, 80, 7247–7312. [Google Scholar] [CrossRef]
- Czaja, W.K.; Young, D.J.; Kawecki, M.; Brown, R.M. The future prospects of microbial cellulose in biomedical applications. Biomacromolecules 2007, 8, 1–12. [Google Scholar] [CrossRef]
- Yamada, Y.; Yukphan, P.; Thi, H.; Vu, L.; Muramatsu, Y.; Ochaikul, D.; Tanasupawat, S.; Nakagawa, Y. Short Communication Description of Komagataeibacter gen. nov., with proposals of new combinations (Acetobacteraceae). J. Gen. Appl. Microbiol. 2012, 58, 397–404. [Google Scholar] [CrossRef]
- Sharma, C.; Bhardwaj, N.K.; Pathak, P. Static intermittent fed-batch production of bacterial nanocellulose from black tea and its modification using chitosan to develop antibacterial green packaging material. J. Clean. Prod. 2021, 279, 123608. [Google Scholar] [CrossRef]
- Abba, M.; Abdullahi, M.; Nor, M.H.M.; Chong, C.S.; Ibrahim, Z. Isolation and characterisation of locally isolated Gluconacetobacter xylinus BCZM sp. with nanocellulose producing potentials. IET Nanobiotechnol. 2018, 12, 52–56. [Google Scholar] [CrossRef]
- Thakur, P.; Mehta, P.; Gupta, N. An Impact Study of Food Product Packaging on Consumer Buying Behaviour: A Study Premise to Himachal Pradesh-India. Int. J. Bio-Resour. Stress Manag. 2017, 8, 882–886. [Google Scholar] [CrossRef]
- Betlej, I.; Salerno-Kochan, R.; Jankowska, A.; Krajewski, K.; Wilkowski, J.; Rybak, K.; Nowacka, M.; Boruszewski, P.; Tanzi, C. The Impact of the Mechanical Modification of Bacterial Cellulose Films on Selected Quality Parameters. Coatings 2021, 11, 1275. [Google Scholar] [CrossRef]
- Betlej, I.; Zakaria, S.; Krajewski, K.; Malays, P.B.-S. Bacterial cellulose–properties and its potential application. Biotechnol. Adv. 2021, 53, 107856. [Google Scholar] [CrossRef]
- Lu, T.; Gao, H.; Liao, B.; Wu, J.; Zhang, W.; Huang, J.; Liu, M.; Huang, J.; Chang, Z.; Jin, M.; et al. Characterization and optimization of production of bacterial cellulose from strain CGMCC 17276 based on whole-genome analysis. Carbohydr. Polym. 2020, 232, 115788. [Google Scholar] [CrossRef]
- El-Gendi, H.; Taha, T.H.; Ray, J.B.; Saleh, A.K. Recent advances in bacterial cellulose: A low-cost effective production media, optimization strategies and applications. Cellulose 2022, 29, 7495–7533. [Google Scholar] [CrossRef]
- Algar, I.; Fernandes, S.C.M.; Mondragon, G.; Castro, C.; Garcia-Astrain, C.; Gabilondo, N.; Retegi, A.; Eceiza, A. Pineapple agroindustrial residues for the production of high value bacterial cellulose with different morphologies. J. Appl. Polym. Sci. 2015, 132, 41237. [Google Scholar] [CrossRef]
- Hestrin, S.; Schramm, M. Synthesis of cellulose by Acetobacter xylinum. 2. Preparation of freeze-dried cells capable of polymerizing glucose to cellulose. Biochem. J. 1954, 58, 345–352. [Google Scholar] [CrossRef]
- Mohammadkazemi, F.; Azin, M.; Ashori, A. Production of bacterial cellulose using different carbon sources and culture media. Carbohydr. Polym. 2015, 117, 518–523. [Google Scholar] [CrossRef]
- Ezejiofor, R.A.; Emmanuel, E.; Olise, M.C. The Relevance of Accounting Records in Small Scale Business: The Nigerian Experience. Int. J. Acad. Res. Bus. Soc. Sci. 2014, 4. [Google Scholar] [CrossRef]
- Sadh, P.K.; Duhan, S.; Duhan, J.S. Agro-industrial wastes and their utilization using solid state fermentation: A review. Bioresour. Bioprocess. 2018, 5, 1. [Google Scholar] [CrossRef]
- Gutiérrez, A.; Palos, R. Green Chemistry: From Wastes to Value-Added Products. Processes 2023, 11, 2131. [Google Scholar] [CrossRef]
- Gelin, K.; Bodin, A.; Gatenholm, P.; Mihranyan, A.; Edwards, K.; Strømme, M. Characterization of water in bacterial cellulose using dielectric spectroscopy and electron microscopy. Polymer 2007, 48, 7623–7631. [Google Scholar] [CrossRef]
- Shah, N.; Ul-Islam, M.; Khattak, W.A.; Park, J.K. Overview of bacterial cellulose composites: A multipurpose advanced material. Carbohydr. Polym. 2013, 98, 1585–1598. [Google Scholar] [CrossRef]
- Siró, I.; Plackett, D. Microfibrillated cellulose and new nanocomposite materials: A review. Cellulose 2010, 17, 459–494. [Google Scholar] [CrossRef]
- Saleh, A.K.; Ray, J.B.; El-Sayed, M.H.; Alalawy, A.I.; Omer, N.; Abdelaziz, M.A.; Abouzeid, R. Functionalization of bacterial cellulose: Exploring diverse applications and biomedical innovations: A review. Int. J. Biol. Macromol. 2024, 264, 130454. [Google Scholar] [CrossRef]
- Ellinas, K.; Tserepi, A.; Gogolides, E. Durable superhydrophobic and superamphiphobic polymeric surfaces and their applications: A review. Adv. Colloid Interface Sci. 2017, 250, 132–157. [Google Scholar] [CrossRef]
- Bhushan, B.; Martin, S. Substrate-independent superliquiphobic coatings for water, oil, and surfactant repellency: An overview. J Colloid Interface Sci. 2018, 526, 90–105. [Google Scholar] [CrossRef] [PubMed]
- Nioras, D.; Gogolides, E.; Ellinas, K. Durable Surfaces of Both Wettability Extremes with Stable Dew Harvesting Performance During Liquid-Vapor-Phase Transitions. Ind. Eng. Chem. Res. 2024, 63, 20872–20882. [Google Scholar] [CrossRef]
- Tselepi, V.; Nioras, D.; Filippou, I.; Ellinas, K. Ultra-thin, thermal diodes incorporating surfaces of extreme wettability, for phase change, heat transfer applications. Appl. Therm. Eng. 2025, 272, 126419. [Google Scholar] [CrossRef]
- Sarkiris, P.; Constantoudis, V.; Ellinas, K.; Lam, C.W.E.; Milionis, A.; Anagnostopoulos, J.; Poulikakos, D.; Gogolides, E. Topography Optimization for Sustainable Dropwise Condensation: The Critical Role of Correlation Length. Adv. Funct. Mater. 2024, 34, 2306756. [Google Scholar] [CrossRef]
- Tzianou, M.; Thomopoulos, G.; Vourdas, N.; Ellinas, K.; Gogolides, E. Tailoring Wetting Properties at Extremes States to Obtain Antifogging Functionality. Adv. Funct. Mater. 2021, 31, 2006687. [Google Scholar] [CrossRef]
- Tselepi, V.; Sarkiris, P.; Nioras, D.; Tsouko, E.; Sarris, D.; Gogolides, E.; Ellinas, K. Functional Surfaces for Passive Fungal Proliferation Control: Effect of Surface Micro- and Nanotopography, Material, and Wetting Properties. ACS Appl. Bio. Mater. 2024, 7, 4510–4518. [Google Scholar] [CrossRef] [PubMed]
- Tsougeni, K.; Ellinas, K.; Koukouvinos, G.; Petrou, P.S.; Tserepi, A.; Kakabakos, S.E.; Gogolides, E. Three-dimensional (3D) plasma micro-nanotextured slides for high performance biomolecule microarrays: Comparison with epoxy-silane coated glass slides. Colloids Surf. B Biointerfaces 2018, 165, 270–277. [Google Scholar] [CrossRef] [PubMed]
- Chen, H.H.; Chen, L.C.; Huang, H.C.; Lin, S.B. In situ modification of bacterial cellulose nanostructure by adding CMC during the growth of Gluconacetobacter xylinus. Cellulose 2011, 18, 1573–1583. [Google Scholar] [CrossRef]
- Fatima, A.; Ortiz-Albo, P.; Neves, L.A.; Nascimento, F.X.; Crespo, J.G. Biosynthesis and characterization of bacterial cellulose membranes presenting relevant characteristics for air/gas filtration. J. Memb. Sci. 2023, 674, 121509. [Google Scholar] [CrossRef]
- Imanbekova, M.; Abbasi, R.; Hu, X.; Sharma, M.; Vandewynckele-Bossut, M.; Haldavnekar, R.; Wachsmann-Hogiu, S. Physical Modifications of Kombucha-Derived Bacterial Nanocellulose: Toward a Functional Bionanocomposite Platform. Macromol. Mater. Eng. 2024, 309, 2400041. [Google Scholar] [CrossRef]
- Amin Ojagh, S.M.; Vahabzadeh, F.; Fallah, N.; Lan, X.; Adesida, A.B.; Kamkar, M.; van de Ven, T.G.M.; Koshani, R. Highly functionalized all-cellulose nanocomposites via bacteria-enabled in-situ modifications. Chem. Eng. J. 2024, 498, 155409. [Google Scholar] [CrossRef]
- Ogrizek, L.; Lamovšek, J.; Primc, G.; Leskovšek, M.; Vesel, A.; Mozetič, M.; Gorjanc, M. Improved Adhesion of Bacterial Cellulose on Plasma-Treated Cotton Fabric for Development of All-Cellulose Biocomposites. Molecules 2024, 29, 5009. [Google Scholar] [CrossRef]
- Liu, Y.; Zhang, M.; Shen, Z.; Li, N.; Mo, X.; Guo, J.; You, B.; Wu, L. Design of honeycomb-imitated composite hydrophobic aerogel and applications for multifunctional water cleaning. Sep. Purif. Technol. 2025, 359, 130341. [Google Scholar] [CrossRef]
- Lin, S.P.; Hong, L.; Hsieh, C.C.; Lin, Y.H.; Chou, Y.C.; Santoso, S.P.; Hsieh, C.W.; Tsai, T.Y.; Cheng, K.C. In situ modification of foaming bacterial cellulose with chitosan and its application to active food packaging. Int. J. Biol. Macromol. 2024, 279, 135114. [Google Scholar] [CrossRef]
- Cai, Z.; Kim, J. Preparation and characterization of novel bacterial cellulose/gelatin scaffold for tissue regeneration using bacterial cellulose hydrogel. J. Nanotechnol. Eng. Med. 2010, 1, 021002. [Google Scholar] [CrossRef]
- Frota, M.M.; Miranda, K.W.E.; Marques, V.S.; Miguel, T.B.A.R.; Mattos, A.L.A.; Miguel, E.d.C.; Santos, N.L.; dos Souza, T.M.; de Salomão, F.C.C.S.; Farias, P.M.; et al. Modified bacterial nanofibril for application in superhydrophobic coating of food packaging. Surf. Interfaces 2024, 46, 103991. [Google Scholar] [CrossRef]
- Li, J.; Liu, Y.; Gu, Z.; Sun, P.; Liu, K.; Xu, D.; Gao, C.; Xu, W. Scalable, Green, Flexible Photochromic Bacterial Cellulose for Multicolor Switching, Photo-patterning, and Daily Sunlight UV Monitoring. Small 2024, 20, e2309514. [Google Scholar] [CrossRef]
- Bottan, S.; Robotti, F.; Jayathissa, P.; Hegglin, A.; Bahamonde, N.; Heredia-Guerrero, J.A.; Bayer, I.S.; Scarpellini, A.; Merker, H.; Lindenblatt, N.; et al. Surface-structured bacterial cellulose with guided assembly-based biolithography (GAB). ACS Nano 2015, 9, 206–219. [Google Scholar] [CrossRef]
- Abol-Fotouh, D.; Al-Hagar, O.E.A.; Roig, A. In situ shaping of intricated 3D bacterial cellulose constructs using sacrificial agarose and diverted oxygen inflow. Carbohydr. Polym. 2024, 343, 122495. [Google Scholar] [CrossRef] [PubMed]
- Roig-Sanchez, S.; Fernández-Sánchez, C.; Laromaine, A.; Roig, A. Bio and soft-imprinting lithography on bacterial cellulose films. Mater. Today Chem. 2021, 21, 100535. [Google Scholar] [CrossRef]
- Bryszewska, M.A.; Pareja, D.G.; Kaczmarek, L.; Sobczyk-Guzenda, A.; Piotrowska, M.; Batory, D. SCOBY Cellulose-Based Materials Hydrophobized Using Stearic Acid and Apple Powder. Int. J. Mol. Sci. 2024, 25, 13746. [Google Scholar] [CrossRef] [PubMed]
- Wang, X.; Feng, X.; Li, Q.; Dong, Z. Surface Functionalization Strategy for Cellulose Membranes Based on Silanization and Thiol-Ene Click Chemistry. ACS Appl. Polym. Mater. 2024, 6, 12992–13001. [Google Scholar] [CrossRef]
- Sommer, A.; Dederko-Kantowicz, P.; Staroszczyk, H.; Sommer, S.; Michalec, M. Enzymatic and chemical cross-linking of bacterial cellulose/fish collagen composites—A comparative study. Int. J. Mol. Sci. 2021, 22, 3346. [Google Scholar] [CrossRef] [PubMed]
- Oliveira Barud, H.G.; Barud, H.D.S.; Cavicchioli, M.; Do Amaral, T.S.; De Oliveira Junior, O.B.; Santos, D.M.; De Oliveira Almeida Petersen, A.L.; Celes, F.; Borges, V.M.; De Oliveira, C.I.; et al. Preparation and characterization of a bacterial cellulose/silk fibroin sponge scaffold for tissue regeneration. Carbohydr. Polym. 2015, 128, 41–51. [Google Scholar] [CrossRef]
- Deng, L.; Li, F.; Han, Z.; Qu, X.; Li, J.; Zhou, Z.; Chen, S.; Wang, H.; Lv, X. Bacterial cellulose-based hydrogel with regulated rehydration and enhanced antibacterial activity for wound healing. Int. J. Biol. Macromol. 2024, 267, 131291. [Google Scholar] [CrossRef]
- Torgbo, S.; Sukyai, P. Bacterial cellulose-based scaffold materials for bone tissue engineering. Appl. Mater. Today 2018, 11, 34–49. [Google Scholar] [CrossRef]
- Ioannou, D.; Hou, Y.; Shah, P.; Ellinas, K.; Kappl, M.; Sapalidis, A.; Constantoudis, V.; Butt, H.J.; Gogolides, E. Plasma-Induced Superhydrophobicity as a Green Technology for Enhanced Air Gap Membrane Distillation. ACS Appl. Mater. Interfaces 2023, 15, 18493–18504. [Google Scholar] [CrossRef]
- Fernandes, M.; Alves, C.; Melro, L.; Fernandes, R.D.V.; Padrão, J.; Salgado, A.J.; Zille, A. Modification of Nanocellulose. In Handbook of Biomass; Springer Nature: Singapore, 2023; pp. 1–39. [Google Scholar] [CrossRef]
- Salimi, S.; Sotudeh-Gharebagh, R.; Zarghami, R.; Chan, S.Y.; Yuen, K.H. Production of Nanocellulose and Its Applications in Drug Delivery: A Critical Review. ACS Sustain. Chem. Eng. 2019, 7, 15800–15827. [Google Scholar] [CrossRef]
- Oberlintner, A.; Likozar, B.; Novak, U. Hydrophobic functionalization reactions of structured cellulose nanomaterials: Mechanisms, kinetics and in silico multi-scale models. Carbohydr. Polym. 2021, 259, 117742. [Google Scholar] [CrossRef]
- Żywicka, A.; Ciecholewska-Juśko, D.; Charęza, M.; Drozd, R.; Sobolewski, P.; Junka, A.; Gorgieva, S.; El Fray, M.; Fijałkowski, K. Argon plasma-modified bacterial cellulose filters for protection against respiratory pathogens. Carbohydr. Polym. 2023, 302, 120322. [Google Scholar] [CrossRef]
- Rolim, A.A.I.; Steffen, T.T.; Becker, D.; Leite, L.R.; Sagás, J.C.; Fontana, L.C.; Bond, D. Plasma surface treatment of bacterial cellulose to increase hydrophobicity. Cellulose 2024, 31, 4817–4831. [Google Scholar] [CrossRef]
- Vasil’kov, A.; Budnikov, A.; Gromovykh, T.; Pigaleva, M.; Sadykova, V.; Arkharova, N.; Naumkin, A. Effect of Bacterial Cellulose Plasma Treatment on the Biological Activity of Ag Nanoparticles Deposited Using Magnetron Deposition. Polymers 2022, 14, 3907. [Google Scholar] [CrossRef] [PubMed]
- Pertile, R.A.N.; Andrade, F.K.; Alves, C.; Gama, M. Surface modification of bacterial cellulose by nitrogen-containing plasma for improved interaction with cells. Carbohydr. Polym. 2010, 82, 692–698. [Google Scholar] [CrossRef]
- Janpetch, N.; Saito, N.; Rujiravanit, R. Fabrication of bacterial cellulose-ZnO composite via solution plasma process for antibacterial applications. Carbohydr. Polym. 2016, 148, 335–344. [Google Scholar] [CrossRef] [PubMed]
- Leal, S.; Cristelo, C.; Silvestre, S.; Fortunato, E.; Sousa, A.; Alves, A.; Correia, D.M.; Lanceros-Mendez, S.; Gama, M. Hydrophobic modification of bacterial cellulose using oxygen plasma treatment and chemical vapor deposition. Cellulose 2020, 27, 10733–10746. [Google Scholar] [CrossRef]
- Andrea, F.; Fernanda de Santana Costa, A.; Sarubbo, L.; Fernanda Santana Costa, A.D.E.; Alice Vasconcelos Rocha, M.; Asfora Sarubbo, L. Review-Bacterial Cellulose: An Ecofriendly Biotextile. Int. J. Text. Fash. Technol. (IJTFT) 2017, 7, 11–26. [Google Scholar]
- Matouk, Z.; Torriss, B.; Rincón, R.; Dorris, A.; Beck, S.; Berry, R.M.; Chaker, M. Functionalization of cellulose nanocrystal films using Non-Thermal atmospheric –Pressure plasmas. Appl. Surf. Sci. 2020, 511, 145566. [Google Scholar] [CrossRef]
- Xu, Y.; Zhang, K.; Zhao, Y.; Li, C.; Su, H.; Huang, C. High-barrier, flexible, hydrophobic, and biodegradable cellulose-based films prepared by ascorbic acid regeneration and low temperature plasma technologies. J. Colloid Interface Sci. 2025, 677, 390–399. [Google Scholar] [CrossRef]
- Babaei, S.; Profili, J.; Al Rashidi, M.; Dorris, A.; Beck, S.; Asadollahi, S.; Sarkissian, A.; Stafford, L. Permeation properties of a plasma-processed organosilicon–carboxymethylcellulose bilayer on fibrillated cellulosic films for sustainable packaging applications. Cellulose 2023, 30, 7889–7904. [Google Scholar] [CrossRef]
- Bhanthumnavin, W.; Wanichapichart, P.; Taweepreeda, W.; Sirijarukula, S.; Paosawatyanyong, B. Surface modification of bacterial cellulose membrane by oxygen plasma treatment. Surf Coat Technol. 2016, 306, 272–278. [Google Scholar] [CrossRef]
- Kirdponpattara, S.; Newby, B.Z.; Phisalaphong, M.K.M. Effect of oxygen plasma treatment on bacterial cellulose-alginate composite sponge as a yeast cell carrier for ethanol fermentation. Adv. Mat. Res. 2013, 724–725, 1150–1153. [Google Scholar] [CrossRef]
- Orlando, I.; Basnett, P.; Nigmatullin, R.; Wang, W.; Knowles, J.C.; Roy, I. Chemical Modification of Bacterial Cellulose for the Development of an Antibacterial Wound Dressing. Front. Bioeng. Biotechnol. 2020, 8, 557885. [Google Scholar] [CrossRef] [PubMed]
- Yazdanbakhsh, M.F.; Rashidi, A.; Rahimi, M.K.; Khajavi, R.; Shafaroodi, H. The Effect of Impregnated Alpha-Cellulose Nanofibers with Ciprofloxacin Hydrochloride on Staphylococcus aureus In Vitro and Healing Process of Wound in Rat. Regen. Eng. Transl. Med. 2018, 4, 247–256. [Google Scholar] [CrossRef]
- Hivechi, A.; Yousefmoumji, H.; Bahrami, S.H.; Brouki Milan, P. Fabrication and characterization of in situ gelling oxidized carboxymethyl cellulose/gelatin nanofibers for wound healing applications. Int. J. Biol. Macromol. 2025, 298, 140033. [Google Scholar] [CrossRef]
- Madani, M.; Cruz, C.D.; Gounani, Z.; Baniasadi, H.; Tammela, P.; Laaksonen, T.; Niskanen, J.; Seppälä, J. Functionalized cellulose nanocrystals reinforced PLA-gelatin electrospun fibers for potential antibacterial wound dressing and coating applications. Int. J. Biol. Macromol. 2025, 287, 138389. [Google Scholar] [CrossRef]
- Patel, D.K.; Dutta, S.D.; Hexiu, J.; Ganguly, K.; Lim, K.T. Bioactive electrospun nanocomposite scaffolds of poly(lactic acid)/cellulose nanocrystals for bone tissue engineering. Int. J. Biol. Macromol. 2020, 162, 1429–1441. [Google Scholar] [CrossRef]
- Wasim, M. An Overview of Synthesized Bacterial Cellulose Nanocomposites for Biomedical Applications. Biomed. J. Sci. Tech. Res. 2020, 27, 20653–20656. [Google Scholar] [CrossRef]
- Mira-Cuenca, C.; Meslier, T.; Roig-Sanchez, S.; Laromaine, A.; Roig, A. Patterning Bacterial Cellulose Films with Iron Oxide Nanoparticles and Magnetic Resonance Imaging Monitoring. ACS Appl. Polym. Mater. 2021, 3, 4959–4965. [Google Scholar] [CrossRef]
- Li, Z.L.; Chen, K.; Li, F.; Shi, Z.J.; Sun, Q.L.; Li, P.Q.; Peng, Y.G.; Huang, L.X.; Yang, G.; Zheng, H.; et al. Decorated bacteria-cellulose ultrasonic metasurface. Nat. Commun. 2023, 14, 5319. [Google Scholar] [CrossRef]
- Than-ardna, B.; Weder, C.; Manuspiya, H. Superhydrophilic bacterial cellulose membranes efficiently separate oil-in-water emulsions. J. Mater. Sci. 2023, 58, 5086–5103. [Google Scholar] [CrossRef]
- Taniyama, H.; Takagi, K. Controlling the surface structure and functionalization of a cellulose nanocrystal film modified by using glycidyloxypropylsilane in a coating process. Polym. J. 2023, 55, 675–682. [Google Scholar] [CrossRef]
- Liu, H.; Hu, Y.; Wu, X.; Hu, R.; Liu, Y.; Moseley, R.; Liu, H.; Hu, Y.; Wu, X.; Hu, R.; et al. Optimization of Surface-Engineered Micropatterns on Bacterial Cellulose for Guided Scar-Free Skin Wound Healing. Biomolecules 2023, 13, 793. [Google Scholar] [CrossRef] [PubMed]
- Costa, L.; Carvalho, A.F.; Silva-Carvalho, R.; Rodrigues, A.C.; Dourado, F.; Deuermeier, J.; Neto, M.A.; Fernandes, A.J.S.; Gama, M.; Costa, F.M. Laser-patterning bacterial nanocellulose for cell-controlled interaction. Cellulose 2024, 31, 8479–8499. [Google Scholar] [CrossRef]
- Jing, W.; Chunxi, Y.; Yizao, W.; Honglin, L.; Fang, H.; Kerong, D.; Yuan, H. Laser patterning of bacterial cellulose hydrogel and its modification with gelatin and hydroxyapatite for bone tissue engineering. Soft Mater. 2013, 11, 173–180. [Google Scholar] [CrossRef]
- Hu, Y.; Liu, H.; Zhou, X.; Pan, H.; Wu, X.; Abidi, N.; Zhu, Y.; Wang, J. Surface engineering of spongy bacterial cellulose via constructing crossed groove/column micropattern by low-energy, CO2 laser photolithography toward scar-free wound healing. Mater. Sci. Eng. C 2019, 99, 333–343. [Google Scholar] [CrossRef]
- Ganner, T.; Sattelkow, J.; Rumpf, B.; Eibinger, M.; Reishofer, D.; Winkler, R.; Nidetzky, B.; Spirk, S.; Plank, H. Direct-Write Fabrication of Cellulose Nano-Structures via Focused Electron Beam Induced Nanosynthesis. Sci. Rep. 2016, 6, srep32451. [Google Scholar] [CrossRef]
- Espinha, A.; Dore, C.; Matricardi, C.; Alonso, M.I.; Goñi, A.R.; Mihi, A. Hydroxypropyl cellulose photonic architectures by soft nanoimprinting lithography. Nat. Photonics 2018, 12, 343–348. [Google Scholar] [CrossRef]
- Zhou, Y.; Li, Y.; Dundar, F.; Carter, K.R.; Watkins, J.J. Fabrication of patterned cellulose film via solvent-assisted soft nanoimprint lithography at a submicron scale. Cellulose 2018, 25, 5185–5194. [Google Scholar] [CrossRef]
- Gregory, D.A.; Tripathi, L.; Fricker, A.T.R.; Asare, E.; Orlando, I.; Raghavendran, V.; Roy, I. Bacterial cellulose: A smart biomaterial with diverse applications. Mater. Sci. Eng. R Rep. 2021, 145, 100623. [Google Scholar] [CrossRef]
- Busuioc, C.; Isopencu, G.; Banciu, A.; Banciu, D.-D.; Oprea, O.; Mocanu, A.; Deleanu, I.; Zăule¸tzăule¸t, M.; Popescu, L.; Tănăsuică, R.; et al. Bacterial cellulose hybrid composites with calcium phosphate for bone tissue regeneration. Int. J. Mol. Sci. 2022, 23, 16180. [Google Scholar] [CrossRef] [PubMed]
- Carvalho, T.; Guedes, G.; Sousa, F.L.; Freire, C.S.R.; Santos, H.A. Latest advances on bacterial cellulose-based materials for wound healing, delivery systems, and tissue engineering. Biotechnol. J. 2019, 14, e1900059. [Google Scholar] [CrossRef]
- Picheth, G.; Pirich, C.L.; Sierakowski, M.R.; Woehl, M.A.; Sakakibara, C.N.; de Souza, C.F.; Martin, A.A. Bacterial cellulose in biomedical applications: A review. Int. J. Biol. Macromol. 2017, 104, 97–106. [Google Scholar] [CrossRef] [PubMed]
- Iacob, A.T.; Drăgan, M.; Ionescu, O.M.; Profire, L.; Ficai, A.; Andronescu, E.; Confederat, L.G.; Lupașcu, D. An overview of biopolymeric electrospun nanofibers based on polysaccharides for wound healing management. Pharmaceutics 2020, 12, 983. [Google Scholar] [CrossRef]
- Dourado, F.; Gama, M.; Rodrigues, A.C. A Review on the toxicology and dietetic role of bacterial cellulose. Toxicol. Rep. 2017, 4, 543–553. [Google Scholar] [CrossRef]
- Shi, Z.; Zhang, Y.; Phillips, G.O.; Yang, G. Utilization of bacterial cellulose in food. Food Hydrocoll. 2014, 35, 539–545. [Google Scholar] [CrossRef]
- Jang, E.J.; Padhan, B.; Patel, M.; Pandey, J.K.; Xu, B.; Patel, R. Antibacterial and biodegradable food packaging film from bacterial cellulose. Food Control. 2023, 153, 109902. [Google Scholar] [CrossRef]
- Lu, Y.; Yuan, W. Superhydrophobic/Superoleophilic and Reinforced Ethyl Cellulose Sponges for Oil/Water Separation: Synergistic Strategies of Cross-linking, Carbon Nanotube Composite, and Nanosilica Modification. ACS Appl. Mater. Interfaces 2017, 9, 29167–29176. [Google Scholar] [CrossRef] [PubMed]
- Ao, C.; Zhao, J.; Li, Q.; Zhang, J.; Huang, B.; Wang, Q.; Gai, J.; Chen, Z.; Zhang, W.; Lu, C. Biodegradable all-cellulose composite membranes for simultaneous oil/water separation and dye removal from water. Carbohydr. Polym. 2020, 250, 116872. [Google Scholar] [CrossRef]
- Fujita, S.; Sasa, R.; Kinoshita, N.; Kishimoto, R.; Kono, H. Nano-Fibrillated Bacterial Cellulose Nanofiber Surface Modification with EDTA for the Effective Removal of Heavy Metal Ions in Aqueous Solutions. Materials 2025, 18, 374. [Google Scholar] [CrossRef]
- Ashour, R.M.; Abdel-Magied, A.F.; Wu, Q.; Olsson, R.T.; Forsberg, K. Green Synthesis of Metal-Organic Framework Bacterial Cellulose Nanocomposites for Separation Applications. Polymers 2020, 12, 1104. [Google Scholar] [CrossRef]
- Cheng, Z.; Li, J.; Wang, B.; Zeng, J.; Xu, J.; Gao, W.; Zhu, S.; Hu, F.; Dong, J.; Chen, K. Scalable and Robust Bacterial Cellulose Carbon Aerogels as Reusable Absorbents for High-Efficiency Oil/Water Separation. ACS Appl. Bio. Mater. 2020, 3, 7483–7491. [Google Scholar] [CrossRef]
- Wang, F.-P.; Zhao, X.-J.; Wahid, F.; Zhao, X.-Q.; Qin, X.-T.; Bai, H.; Xie, Y.-Y.; Zhong, C.; Jia, S.-R. Sustainable, superhydrophobic membranes based on bacterial cellulose for gravity-driven oil/water separation. Carbohydr. Polym. 2021, 253, 117220. [Google Scholar] [CrossRef] [PubMed]
- He, J.; Zhao, H.; Li, X.; Su, D.; Zhang, F.; Ji, H.; Liu, R. Superelastic and superhydrophobic bacterial cellulose/silica aerogels with hierarchical cellular structure for oil absorption and recovery. J. Hazard. Mater. 2018, 346, 199–207. [Google Scholar] [CrossRef] [PubMed]
- Sai, H.; Fu, R.; Xing, L.; Xiang, J.; Li, Z.; Li, F.; Zhang, T. Surface modification of bacterial cellulose aerogels’ web-like skeleton for oil/water separation. ACS Appl. Mater. Interfaces 2015, 7, 7373–7381. [Google Scholar] [CrossRef]
- Xu, Y.; Zhang, Z.; Cui, Z.; Luo, L.; Lin, P.; Xie, M.; Zhang, Q.; Sa, B.; Wen, C. Enhanced interfacial interactions and enriched active sites in self-assembly amino-functionalized bacterial cellulose/MXene composite for wastewater treatment. Chem. Eng. J. 2024, 488, 151078. [Google Scholar] [CrossRef]
- Guo, Y.; Li, M.; Zhou, T.; Wu, Q.; Liu, C.; Li, S.; Feng, Q.; Wang, H.; Li, Z. Environmentally friendly bacterial cellulose hydrogel-derived aerogel and membrane for efficient water purification. J. Environ. Chem. Eng. 2025, 13, 116023. [Google Scholar] [CrossRef]
- Yang, J.; Xu, H.; Zhang, L.; Zhong, Y.; Sui, X.; Mao, Z. Lasting superhydrophobicity and antibacterial activity of Cu nanoparticles immobilized on the surface of dopamine modified cotton fabrics. Surf. Coatings Technol. 2017, 309, 149–154. [Google Scholar] [CrossRef]
- Asim, N.; Badiei, M.; Mohammad, M. Recent advances in cellulose-based hydrophobic food packaging. Emergent Mater. 2022, 5, 703–718. [Google Scholar] [CrossRef]
- Wang, J.; Euring, M.; Ostendorf, K.; Zhang, K. Biobased materials for food packaging. J. Bioresour. Bioprod. 2022, 7, 1–13. [Google Scholar] [CrossRef]
- Jokar, M.; Montazer, M.; Hemmatinejad, N.; Rad, M.M. Bacterial cellulose nanofibers layer with water-floating, photothermal, bio- and electro-active features. Carbohydr. Polym. Technol. Appl. 2025, 9, 100618. [Google Scholar] [CrossRef]
- Tyagi, N.; Thangadurai, P.; Suresh, S. Application of bacterial cellulose–silver nanoprism composite for detoxification of endosulfan and inactivation of Escherichia coli cells. Int. J. Environ. Sci. Technol. 2020, 17, 1713–1726. [Google Scholar] [CrossRef]
- Pal, S.; Nisi, R.; Stoppa, M.; Licciulli, A. Silver-Functionalized Bacterial Cellulose as Antibacterial Membrane for Wound-Healing Applications. ACS Omega 2017, 2, 3632–3639. [Google Scholar] [CrossRef]
- Shao, W.; Wu, J.; Liu, H.; Ye, S.; Jiang, L.; Liu, X. Novel bioactive surface functionalization of bacterial cellulose membrane. Carbohydr. Polym. 2017, 178, 270–276. [Google Scholar] [CrossRef]
- Fernandes, S.C.M.; Sadocco, P.; Alonso-Varona, A.; Palomares, T.; Eceiza, A.; Silvestre, A.J.D.; Mondragon, I.; Freire, C.S.R. Bioinspired antimicrobial and biocompatible bacterial cellulose membranes obtained by surface functionalization with aminoalkyl groups. ACS Appl. Mater. Interfaces 2013, 5, 3290–3297. [Google Scholar] [CrossRef] [PubMed]
- Qiu, Y.; Zhang, Z.; Liang, S.; Miao, Y.; Yao, C. Preparation of fluorine-free and stable superhydrophobic paper for packaging. J. Wood Chem. Technol. 2022, 42, 222–234. [Google Scholar] [CrossRef]
- Crane, M.J.; Henry, W.L.; Tran, H.L.; Albina, J.E.; Jamieson, A.M. Assessment of acute wound healing using the dorsal subcutaneous polyvinyl alcohol sponge implantation and excisional tail skin wound models. J. Visualized Exp. 2020, 2020, e60653. [Google Scholar] [CrossRef]
- Fernandes, I.d.A.A.; Pedro, A.C.; Ribeiro, V.R.; Bortolini, D.G.; Ozaki, M.S.C.; Maciel, G.M.; Haminiuk, C.W.I. Bacterial cellulose: From production optimization to new applications. Int. J. Biol. Macromol. 2020, 164, 2598–2611. [Google Scholar] [CrossRef]
- Sulaeva, I.; Henniges, U.; Rosenau, T.; Potthast, A. Bacterial cellulose as a material for wound treatment: Properties and modifications: A review. Biotechnol. Adv. 2015, 33, 1547–1571. [Google Scholar] [CrossRef] [PubMed]
- Li, Z.; Lv, X.; Chen, S.; Wang, B.; Feng, C.; Xu, Y.; Wang, H. Improved cell infiltration and vascularization of three-dimensional bacterial cellulose nanofibrous scaffolds by template biosynthesis. RSC Adv. 2016, 6, 42229–42239. [Google Scholar] [CrossRef]
- Frone, A.N.; Panaitescu, D.M.; Nicolae, C.A.; Gabor, A.R.; Trusca, R.; Casarica, A.; Stanescu, P.O.; Baciu, D.D.; Salageanu, A. Bacterial cellulose sponges obtained with green cross-linkers for tissue engineering. Mater. Sci. Eng. C 2020, 110, 110740. [Google Scholar] [CrossRef]
- Pang, M.; Huang, Y.; Meng, F.; Zhuang, Y.; Liu, H.; Du, M.; Ma, Q.; Wang, Q.; Chen, Z.; Chen, L.; et al. Application of bacterial cellulose in skin and bone tissue engineering. Eur. Polym. J. 2020, 122, 109365. [Google Scholar] [CrossRef]
- Ul-Islam, M.; Ullah, M.; Khan, S.; Park, J.K. Production of bacterial cellulose from alternative cheap and waste resources: A step for cost reduction with positive environmental aspects. J. Chem. Eng. 2020, 37, 925–937. [Google Scholar] [CrossRef]
- Ullah, H.; Santos, H.A.; Khan, T. Applications of bacterial cellulose in food, cosmetics and drug delivery. Cellulose 2016, 23, 2291–2314. [Google Scholar] [CrossRef]
- Yang, J.; Wang, L.; Zhang, W.; Sun, Z.; Li, Y.; Yang, M.; Zeng, D.; Peng, B.; Zheng, W.; Jiang, X.; et al. Reverse reconstruction and bioprinting of bacterial cellulose-based functional total intervertebral disc for therapeutic implantation. Small 2017, 14, 1702582. [Google Scholar] [CrossRef]
- Wei, B.; Yang, G.; Hong, F. Preparation and evaluation of a kind of bacterial cellulose dry films with antibacterial properties. Carbohydr. Polym. 2011, 84, 533–538. [Google Scholar] [CrossRef]
- Buruaga-Ramiro, C.; Valenzuela, S.V.; Valls, C.; Roncero, M.B.; Pastor, F.I.J.; Díaz, P.; Martinez, J. Development of an antimicrobial bioactive paper made from bacterial cellulose. Int. J. Biol. Macromol. 2020, 158, 587–594. [Google Scholar] [CrossRef]
- Khalid, A.; Madni, A.; Raza, B.; Islam, M.U.; Hassan, A.; Ahmad, F.; Ali, H.; Khan, T.; Wahid, F. Multiwalled carbon nanotubes functionalized bacterial cellulose as an efficient healing material for diabetic wounds. Int. J. Biol. Macromol. 2022, 203, 256–267. [Google Scholar] [CrossRef]
- Deng, L.; Huang, Y.; Chen, S.; Han, Z.; Han, Z.; Jin, M.; Qu, X.; Wang, B.; Wang, H.; Gu, S. Bacterial cellulose-based hydrogel with antibacterial activity and vascularization for wound healing. Carbohydr. Polym. 2023, 308, 120647. [Google Scholar] [CrossRef]
- Aragão, J.V.S.; Costa, A.F.S.; Silva, G.L.; Silva, S.M.; Macêdo, J.S.; Galdino, C.J.S.; Milanez, V.F.A.; Sarubbo, L.A. Analysis of the environmental life cycle of bacterial cellulose production. Chem. Eng. Trans. 2020, 79, 445–450. [Google Scholar] [CrossRef]
- Li, Z.; Wang, L.; Hua, J.; Jia, S.; Zhang, J.; Liu, H. Production of nano bacterial cellulose from waste water of candied jujube-processing industry using Acetobacter xylinum. Carbohydr. Polym. 2015, 120, 115–119. [Google Scholar] [CrossRef]
- Moosavi-Nasab, M.; Yousefi, A.R. Biotechnological production of cellulose by Gluconacetobacter xylinus from agricultural waste. Iranian J. Biotechnol. 2011, 9, 94–101. [Google Scholar]
- Wu, J.; Zheng, Y.; Song, W.; Luan, J.; Wen, X.; Wu, Z.; Chen, X.; Wang, Q.; Guo, S. In situ synthesis of silver-nanoparticles/bacterial cellulose composites for slow-released antimicrobial wound dressing. Carbohydr. Polym. 2014, 102, 762–771. [Google Scholar] [CrossRef]
- Tang, J.; Sisler, J.; Grishkewich, N.; Tam, K.C. Functionalization of cellulose nanocrystals for advanced applications. J. Colloid. Interface Sci. 2017, 494, 397–409. [Google Scholar] [CrossRef]
- Taliantzis, K.; Ellinas, K. Green hydrophobic and superhydrophobic coatings and surfaces for water related applications: A review. Adv. Colloid Interface Sci. 2025, 343, 103566. [Google Scholar] [CrossRef]
- Tahir, D.; Karim, M.R.A.; Hu, H.; Naseem, S.; Rehan, M.; Ahmad, M.; Zhang, M. Sources, Chemical Functionalization, and Commercial Applications of Nanocellulose and Nanocellulose-Based Composites: A Review. Polymers 2022, 14, 4468. [Google Scholar] [CrossRef] [PubMed]
- Brennan, M.E.; Valsami-Jones, E. Safe by Design for Nanomaterials—Late Lessons from Early Warnings for Sustainable Innovation. Nanoethics 2021, 15, 99–103. [Google Scholar] [CrossRef]
- Furxhi, I.; Costa, A.; Vázquez-Campos, S.; Fito-López, C.; Hristozov, D.; Tamayo Ramos, J.A.; Resch, S.; Cioffi, M.; Friedrichs, S.; Rocca, C.; et al. Status, implications and challenges of European safe and sustainable by design paradigms applicable to nanomaterials and advanced materials. RSC Sustain. 2023, 1, 234–250. [Google Scholar] [CrossRef]
Disclaimer/Publisher’s Note: The statements, opinions and data contained in all publications are solely those of the individual author(s) and contributor(s) and not of MDPI and/or the editor(s). MDPI and/or the editor(s) disclaim responsibility for any injury to people or property resulting from any ideas, methods, instructions or products referred to in the content. |
© 2025 by the authors. Licensee MDPI, Basel, Switzerland. This article is an open access article distributed under the terms and conditions of the Creative Commons Attribution (CC BY) license (https://creativecommons.org/licenses/by/4.0/).